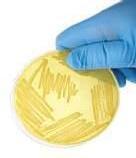
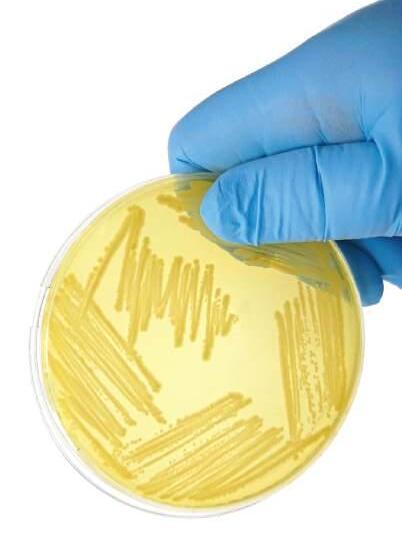

![]()




Os componentes do leite humano criam um ambiente intestinal saudável
Estudo comprova benefícios de zinco e LcS no perfil lipídico de mulheres obesas
Jabuticaba é rica em propriedades nutritivas e mostra potencial terapêutico
Olfato apurado dos cães pode ser utilizado para detectar doenças

Amaternidade traz muitas responsabilidades, em meio a um amor profundo, a muitas alegrias e a um vínculo que dura por toda a vida. E uma das tarefas mais importantes das mães é alimentar os filhos adequadamente para que cresçam fortes e sadios. O primeiro alimento é o leite materno, comprovadamente rico e completo para garantir o crescimento físico e o desenvolvimento cerebral dos bebês. O resultado do aleitamento exclusivo pelos primeiros seis meses também será uma microbiota colonizada por bactérias benéficas que vão garantir um sistema imune íntegro e, consequentemente, uma criança mais protegida de alergias e infecções. Afinal, cada ser humano é exposto a microrganismos o tempo todo, alguns com grande potencial de causar doenças. Por isso, quanto mais protegidos os bebês estiverem desde os primeiros dias de nascimento, mais saudáveis serão ao longo da vida. Para as mães, amamentar protege de diabetes, câncer de mama e ovário, além de diminuir os riscos no pós-parto. Embora a amamentação demande energia e esforço, os benefícios e o vínculo entre mãe e filho sempre valerão a pena. Boa leitura!
A revista Super Saudável é uma publicação da Yakult SA Indústria e Comércio dirigida a profissionais da área da saúde e funcionários.
Coordenação geral: Atsushi Nemoto
Produção editorial e visual: Companhia de Imprensa Divisão Publicações – Telefone (11) 4432-4000
Editora responsável: Adenilde Bringel – MTB 16.649 adbringel@companhiadeimprensa.com.br
Editoração eletrônica: Companhia de Imprensa
Designer gráfico: Renato Borges
Fotografia: Arquivo Yakult
Capa: Depositphotos/NewAfrica
Impressão: Gráfica Oceano
Cartas e contatos: Yakult SA Indústria e Comércio Rua Porangaba, 170 – Bosque da Saúde – São Paulo
CEP 04136-020 – Telefone 0800 0131260 – www.yakult.com.br
Cartas para a Redação: Rua José Versolato, 111 – Cj 1024 Bloco B – Centro – São Bernardo do Campo – SP – CEP 09750-730
DIREITOS RESERVADOS É proibida a reprodução total ou parcial sem prévia autorização da Companhia de Imprensa Divisão Publicações e da Yakult.

10
O leite humano tem uma composição altamente complexa, contendo todos os nutrientes que o bebê precisa nos primeiros meses de vida, e possui uma mistura única de macronutrientes, micronutrientes, enzimas, hormônios e compostos bioativos, além de anticorpos e fatores imunológicos
PROBIÓTICOS & MICROBIOTA 12
Os oligossacarídeos do leite materno são carboidratos complexos não digeríveis que estimulam o crescimento de bactérias protetoras no intestino das crianças
O professor doutor Shaker Chuck Farah explica como as bactérias vivem, se relacionam e se replicam, e de que maneira os vírus bacteriófagos poderão ajudar a combater bactérias resistentes a antibióticos
Versátil e com polpa suculenta, a jabuticaba tem sido objeto de diversas pesquisas que apontam para seu potencial terapêutico, inclusive da casca
O olfato apurado dos cães pode ser utilizado para detectar precocemente problemas de saúde VIDA SAUDÁVEL

Estudo científico mostra efeitos da suplementação de L. casei Shirota e zinco na circunferência da cintura e na gordura corporal de mulheres com obesidade


A cirrose hepática é uma doença crônica e progressiva que acomete o fígado, órgão vital para o funcionamento do corpo humano, e causa milhares de mortes anuais
Estudo sugere microrganismos como peça-chave na etiologia da doença de Parkinson, e relógios inteligentes poderão fornecer uma avaliação dos tremores típicos da enfermidade

O Caminho da Fé, no Brasil, é um convite à reflexão, enquanto o Alentejo, em Portugal, é um verdadeiro tesouro cultural
Yakult renova contrato de patrocínio com CBDA e apoia o Todos pelo Esporte: Só para Elas/SP. Tonyu chega aos 40 anos com mercado consolidado


O LEITE HUMANO É UM COMPLEXO
BIOLÓGICO QUE SALVA
VIDAS, FORTALECE O SISTEMA IMUNOLÓGICO
E É ESSENCIAL PARA O DESENVOLVIMENTO
Elessandra Asevedo
Especial para Super Saudável
AOrganização Mundial da Saúde (OMS) recomenda que os bebês sejam amamentados exclusivamente nos primeiros seis meses de vida. E, se possível, a orientação é manter o aleitamento até os dois anos de idade ou mais – mesmo depois da introdução alimentar. A recomendação se justifica porque o leite materno é o melhor alimento para os bebês, oferecendo todos os nutrientes necessários para uma efetiva proteção contra doenças. O leite humano tem uma composição altamente complexa, contendo todos os nutrientes que o bebê precisa nos primeiros meses de vida. O alimento possui uma mistura única de macronutrientes como proteínas, gorduras e carboidratos; além de micronutrientes, vitaminas, minerais, enzimas, hormônios e compostos bioativos, incluindo anticorpos e fatores imunológicos. No entanto, de acordo com a OMS, apenas 43% das crianças menores de seis meses são amamentadas exclusivamente na América Latina e no Caribe. E a má nutrição durante os estágios iniciais do ciclo de vida pode levar a danos significativos e irreversíveis ao crescimento físico e ao desenvolvimento cerebral.
O leite materno também contém bactérias benéficas, incluindo espécies de Lactobacillus e Bifidobacterium, que ajudam a colonizar o intestino do bebê
e formar uma microbiota saudável –fundamental para o desenvolvimento dos sistemas imunológico, digestivo e neurológico (leia mais na página 10) “A transferência dessas bactérias do leite materno para o bebê contribui para a maturação do microbioma intestinal, protegendo contra infecções e doenças inflamatórias. Além disso, modula reações imunológicas sem causar inflamação excessiva”, afirma a médica pediatra Lélia Cardamone Gouvêa, secretária do Departamento Científico de Aleitamento Materno da Sociedade Brasileira de Pediatria (SBP) e docente da Universidade Santo Amaro (Unisa).
O conteúdo imunológico do leite materno também evolui de acordo com as fases da lactação. Na fase inicial, a concentração de imunoglobulinas secretoras, fatores anti-inflamatórios e células imunologicamente ativas é maior. Já no decurso da lactação, o leite continua a se adaptar às necessidades de proteção imunológica e nutricional do lactente. Com relação à composição do leite em macronutrientes, as proteínas variam entre as mamadas e durante o dia e os lipídios têm maior concentração noturna e também variam com a dieta materna, enquanto os carboidratos se mantêm constantes durante o dia. Os micronutrientes também são influenciados pela dieta materna, com variação circadiana na concentração de alguns minerais como o ferro, que tem o pico de concentração ao meio-dia. Em contrapartida,
magnésio, zinco e potássio alcançam níveis mais elevados pela manhã. A enfermeira Eunice Francisca Martins, professora doutora da Escola de Enfermagem da Universidade Federal de Minas Gerais (UFMG), reforça que o leite materno é completo e fornece todos os nutrientes necessários ao bebê mesmo quando a mãe sofre com desnutrição. “Em países africanos, por exemplo, estudos comprovam que os componentes do leite de mães desnutridas são iguais aos das mulheres que não sofrem com a desnutrição, pois o organismo trabalha para proteger a vida e atender às necessidades do bebê. Por isso, precisamos acabar com o mito de que a criança chora porque o leite da mãe é fraco e não sustenta”, pontua. Na verdade, as mães devem procurar entender por que o bebê tem mamado com maior frequência: se é porque gosta de ficar no colo, se existe difi-
culdade com a ‘pega’ ou mesmo se ocorre a saciedade antes da retirada do leite posterior (do final da mamada e mais rico em gorduras) diante de uma mama com muito leite.
Outro ponto destacado pela enfermeira é que a alimentação da mãe não influencia na composição nutricional do leite materno, mas sim no sabor. No entanto, a orientação é que a mulher mantenha a mesma alimentação de sempre, buscando alimentos saudáveis e alta ingestão de líquidos, e evitando bebidas alcoólicas e gaseificadas. “Não há diferenças significativas entre o leite de mães de diferentes regiões ou contextos socioeconômicos, pois o organismo consegue proporcionar a quantidade de proteína, aminoácidos e vitaminas que atenda à necessidade de cada lactante”, complementa. Da mesma forma, os anticorpos que protegem o bebê estão presentes conforme o histórico da mãe, ou seja, se foi vacinada ou teve alguma infecção. Por isso, é muito importante que a mãe seja devidamente imunizada de acordo com as recomendações dos especialistas que acompanham a gravidez.

A campanha de conscientização Agosto Dourado é dedicada à promoção, proteção e apoio ao aleitamento materno. O mês foi escolhido por ter sido o período em que, em 1990, a OMS e o Fundo das Nações Unidas para a Infância (UNICEF) firmaram a Declaração de Innocenti, que tem como objetivo incentivar políticas públicas e ações que garantam o direito à amamentação por todas as crianças. Já a cor dourada simboliza o

padrão ouro de qualidade do leite materno, considerado o alimento mais completo para os bebês nos primeiros meses de vida. Para possibilitar o contato da mãe com o bebê imediatamente após o parto foi idealizada a ‘hora de ouro’, ou golden hour, que é a primeira hora da mãe com o filho recém-nascido. O objetivo é promover a continuação do vínculo que começou durante a gestação e ajudar o bebê na transição do útero para o ambiente externo
O aleitamento materno está associado a melhores resultados em testes de desenvolvimento cognitivo e habilidades sociais na infância, graças aos ácidos graxos essenciais e a outros nutrientes presentes no leite. Segundo as evidências, crianças que mamaram por mais de seis meses tiveram melhores resultados cognitivos nos primeiros anos de vida, maiores níveis de quociente de inteligência (QI) na infância, melhores notas em testes educacionais na adolescência e maior média salarial na vida adulta. Ao longo da vida, esses indivíduos também apresentaram autorregulação mais elaborada e menos problemas de conduta e psicopatologias frente às exigências sociais.“Esses resultados ligados ao aleitamento materno exclusivo são o reflexo do amplo desenvolvimento de vias cerebrais associadas, principalmente à função de linguagem, memória verbal e tomada de decisões”, ressalta a pediatra Lélia Cardamone Gouvêa.
As bases biológicas para esses efeitos estão centradas nas propriedades nutricionais do leite materno, rico em ácidos graxos

poli-insaturados, glicocorticoides, vitaminas, minerais e micronutrientes, e também ao vínculo mãe-bebê que a amamentação proporciona. A cada mamada, o lactente tem um importante contato pele a pele criando um estímulo sensorial e, ao mamar, tem o contato olho no olho e a interação com a mãe. Já a melatonina, um hormônio produzido pela glândula pineal na mãe e que passa ao leite materno especialmente durante a noite, ajuda a regular o ciclo sono-vigília do bebê promovendo um sono mais tranquilo e consistente. No primeiro mês, a transferência passiva de melatonina pelo leite contribui para o desenvolvimento do ritmo circadiano do bebê, facilitando a iniciação e manutenção do sono, além de influenciar positivamente o desenvolvimento neurológico. Essa é considerada outra importante vantagem dos bebês amamentados, pois recebem a melatonina materna até que consigam produzir sua própria. A melatonina também possui propriedades antioxidantes e moduladoras do sistema imunológico, ajudando a proteger o bebê contra o estresse oxidativo e a inflamação excessiva.
Pesquisas recentes comprovam que bebês amamentados têm menor incidência de infecções respiratórias, diarreia e doenças alérgicas. Segundo a OMS, o aleitamento prolongado reduz em 13% o risco de sobrepeso e obesidade, ajudando a combater doenças não transmissíveis causadas pelo excesso de peso. Além disso, diminui o risco de diabetes tipo 2 em 35%. A entidade garante, ainda, que a amamentação por seis meses ou mais está associada a uma redução de 19% no risco de leucemia infantil – em comparação com um período mais curto ou com crianças não amamentadas. Bebês amamentados também têm risco 60% menor de morrer por síndrome de morte súbita infantil, cujo efeito é ainda maior para crianças com aleitamento exclusivo. Além de proporcionar benefícios nutritivos e imunológicos, o aleitamento pode ajudar no desenvolvimento da respiração, deglutição, fala e mastigação.
Evidências científicas sugerem, ainda, que bebês amamentados no primeiro ano de vida têm menor recorrência de cárie dentária na primeira

infância – que engloba crianças de até seis anos de idade – em relação aos que consomem fórmula infantil. Ao mamar, o bebê também diminui a exposição inadequada ao flúor e evita o consumo precoce de açúcares, impactando diretamente na prevenção da cárie. De acordo com o Ministério da Saúde, enquanto o amamentar promove a sucção correta – essencial para o desenvolvimento de hábitos saudáveis e a formação de uma mordida adequada –, a ausência do aleitamento ou o desmame precoce resultam na falta de estímulos para o desenvolvimento craniofacial. Ademais, a introdução de bicos artificiais, como mamadeiras e chupetas, movimenta uma musculatura diferente da correta e pode ocasionar hipertonia muscular e alterar a estrutura bucal. Já as mulheres que amamentam no período preconizado têm menos risco de diabetes tipo 2 (32%), câncer de mama (26%) e câncer de ovário (37%) em comparação com aquelas que não amamentam ou amamentam menos.
A ginecologista Silvia Regina Piza, presidente da Comissão Nacional Especializada em Aleitamento Materno da Federação Brasileira das Associações de Ginecologia e Obstetrícia (FEBRASGO), acrescenta que o aleitamento materno também é importante pois, além de criar um vínculo com a criança, auxilia na formação da mama que começou na vida embrionária da mulher. “Amamentar ajuda, ainda, na recuperação do útero após o parto porque a sucção do bebê estimula a produção de oxitocina, um hormônio que ajuda o útero a contrair e voltar ao tamanho normal mais rapidamente, reduzindo o risco de hemorragia pós-parto e anemia”, ensina. Ao mesmo tempo, a amenorreia lactacional nos primeiros dias de amamentação dificulta o surgimento de uma nova gestação, pois a liberação
Os principais fatores de risco para câncer de mama são a idade e o histórico familiar, especificamente se a mulher tem um parente de primeiro grau com a doença. Mulheres com histórico de amamentação, no entanto, demonstraram apresentar taxas reduzidas da neoplasia. Embora a causa específica não tenha sido esclarecida, estudos sugerem que a amamentação reduz o risco de desenvolver a enfermidade principalmente por meio de dois mecanismos: a diferenciação do tecido mamário e a redução do número de ciclos ovulatórios ao longo da vida. De acordo com a professora doutora Adenilda Cristina Honório França, orientadora do Programa de Pósgraduação em Ciências de Materiais e coordenadora do Programa de Pós-graduação em Imunologia e Parasitologia Básicas e Aplicadas do Campus Universitário do Araguaia da Universidade Federal de Mato Grosso (UFMT), estudos epidemiológicos comprovam que as mães que amamentam têm um menor índice de câncer de mama e que o leite materno possui ação antitumoral.
“Um trabalho realizado com mães que estavam com câncer de mama e mulheres sem a doença mostrou que as diagnosticadas não

amamentaram ou fizeram por um tempo menor”, resume. Essa ação benéfica do leite materno observada em diferentes trabalhos levou o grupo da UFMT a investigar os componentes presentes no alimento com potencial terapêutico na prevenção da enfermidade. O estudo com apoio da Fundação de Amparo à Pesquisa do Estado de Mato Grosso (Fapemat) faz parte do projeto intitulado ‘Imunobiológicos derivados do leite humano: um produto natural, ecológico e tecnologicamente melhorado para prevenção e tratamento do câncer de mama’. Por exemplo, a imunoglobulina A (IgA), considerada a primeira linha de defesa contra agentes infecciosos que entram no organismo, é encontrada no sangue e na saliva, em altas concentrações no leite materno e também está presente nos sistemas geniturinário, digestivo e respiratório, protegendo-os contra infecções.
Outro componente estudado pelo grupo é a melatonina presente no leite materno, que tem um importante papel na modulação do sistema imunológico do bebê e atua como um potente antioxidante e anti-inflamatório, além de contribuir para a proteção e o fortalecimento do sistema imunológico. Após vários estudos, os resultados
de prolactina inibe a produção de hormônios que estimulam a ovulação e a menstruação.
A professora Eunice Francisca Martins assegura que são poucas as situações em que o aleitamento materno é contraindicado. Um exemplo são as mulheres HIV positivo, que não devem amamentar pelo risco (ainda que pequeno) de o vírus ser transmitido pelo leite. No caso de outras infecções que necessitam de uso de antibiótico pela mãe, a melhor opção é utilizar o medicamento compatível com a amamentação. “Algumas medicações psiquiátricas podem impedir a amamentação, mas os médicos podem avaliar ou trocar temporariamente a prescrição. Medicamentos para tratamento oncológico também podem levar à contraindicação”, orienta.
Do ponto de vista do bebê, a prematuridade pode ser um dos motivos para postergar o aleitamento materno direto da mama. No entanto, o bebê será estimulado na unidade neonatal pela fonoterapeuta até que sua maturidade permita sugar de forma efetiva e se alimentar di-

reto na mama. Neste período, o bebê irá receber o leite materno por sonda. A pediatra Lélia Cardamone Gouvêa diz que cada gota do leite ordenhado ou do banco de leite oferecerá os benefícios capazes de promover sua recuperação, evitando a enterocolite necrotizante (ECN), que é uma das causas de mortalidade elevada nas unidades neonatais. “A introdução precoce de leite materno pode reduzir a incidência da ECN em até 50%, lembrando que a mortalidade pela doença varia entre 20% a 30% em casos graves, especialmente em prematuros de muito baixo peso. Com práticas de prevenção, como a oferta precoce de leite materno, essa mortalidade pode ser reduzida”, reforça.

mostraram que esses elementos apresentaram atividade antitumoral in vitro contra células de câncer de mama. Os pesquisadores acreditam que, em médio prazo, estes componentes possam ter potencial na utilização em tratamentos e terapias para este tipo de câncer e para outras doenças. A proposta é buscar alternativas de inovação tecnológica por meio de bioprocessamento e extração de forma sustentável de componentes imunobiológicos do leite humano. “Também queremos fazer o processo sem a utilização de animais ou com uso restrito, utilizando células e/ou tecidos obtidos por bioimpressão, que poderão ser empregados no desenvolvimento do trabalho”, destaca a pesquisadora Adenilda Cristina Honório França. Além disso, os componentes imunobiológicos para tratamento e prevenção de câncer de mama são extraídos a partir de leite humano proveniente do descarte em bancos de leite. Segundo a pesquisadora, cerca de 30% dos mais de 160 mil litros de leite humano coletados anualmente

Para o bebê conseguir retirar o leite da mama é necessário que consiga coordenar as etapas de sugar, respirar e deglutir. Essa ordem ajuda a garantir que consiga se alimentar de forma eficiente e segura, sem engasgar ou ficar sem respirar. “Um bebê prematuro consegue começar a sugar na mama por volta da 32ª a 34ª semanas de gestação, mas isso pode variar bastante dependendo do grau de prematuridade e do desenvolvimento individual”, acentua a professora Eunice Francisca Martins. Por isso, é importante que a equipe acompanhe de perto, pois alguns prematuros podem precisar de suporte adicional até estarem mais maduros para se alimentar por conta própria.

pela Rede Brasileira de Bancos de Leite Humano são perdidos, principalmente pela forma como é feito o armazenamento e a coleta, e pelo rigoroso controle de qualidade necessário para que o leite seja ofertado aos lactentes.“Portanto, seria uma utilização sustentável e uma importante alternativa para o reaproveitamento do conteúdo de leite descartado, servindo como modelo para procedimentos que podem ser implantados em toda a rede e, eventualmente, até em bancos internacionais”, argumenta. O Brasil possui a maior e mais complexa rede de bancos de leite humano do mundo, com aproximadamente 237 unidades em todas as regiões do País. O leite doado atende recém -nascidos internados em unidades neonatais.

O grupo de Pesquisa Analítica Aplicada a Lipídios, Esteróis e Antioxidantes da Universidade Estadual de Maringá (APLE-A/ UEM), no Paraná, estuda o leite materno há cerca de 15 anos, analisando quais componentes estão em maior concentração e geram mais benefícios. Ao analisar os carboidratos, o grupo obser vou que o 2-fucosilactose (2’-FL) estava presente em grande concentração. Este componente não tem como função somente ser fonte de energia, pois protege contra infecções.
“O 2’-FL age como alimento para vírus e bactérias e se torna atrativo para esses microrganismos, impedindo que se fixem no organismo do bebê. Este carboidrato também alimenta as boas bactérias, tornando a microbiota mais saudável. Além disso, ajuda a amadurecer as células intestinais e modula a resposta imunológica da criança”, afirma o professor doutor Oscar de Oliveira Santos Júnior, pesquisador do Departamento de Química da UEM e responsável pelo grupo.
O 2-fucosilactose é encontrado naturalmente apenas no leite humano em grandes quantidades. Outros mamíferos, como vacas ou cabras, produzem tipos diferentes de açúcares no leite e, geralmente, em quantidades muito menores. No entanto, nem todo leite humano possui este componente. “A presença desse oligossacarídeo depende de um fator genético da mãe e da presença do gene FUT2, chamado de gene secretor. Aproximadamente 70% das mulheres no mundo possuem esse gene ativo e, por isso, produzem naturalmente 2’-FL no leite”, revela o professor. As 30% res-

tantes não produzem o composto, mas, ainda assim, o leite dessas mulheres é rico em outros oligossacarídeos com funções semelhantes.
Atualmente, graças à biotecnologia, o 2’-FL pode ser produzido em laboratório por fermentação com bactérias geneticamente modificadas, como E. coli especiais. Dessa maneira, passou a ser adicionado a algumas fórmulas infantis para tentar imitar os benefícios do leite materno, principalmente para proteger contra infecções e fortalecer o intestino do bebê.
Amamentar é um ato natural, mas nem sempre é fácil, pois exige apoio, informação e empatia para que muitas mães possam superar os desafios físicos, emocionais e sociais. Para a ginecologista Silvia Regina Piza, o preparo para a amamentação deve começar assim que a mulher pensa em gestar. Assim, as informações, pretensões e restrições podem ser discutidas durante todo o período gestacional com o profissional que acompanha a gravidez, e também após o parto. Além disso, o estímulo ao aleitamento envolve questões sociais, culturais e econômicas que, muitas vezes, levam a mulher a desistir de amamentar.
A introdução de frutas e sucos precocemente, muitas vezes apoiada pelos profissionais da saúde, também faz com que ocorram menos mamadas e, consequentemente, menos produção de leite materno e de tempo de aleitamento. “Existe uma pressão social e familiar para introduzir outros alimentos antes dos seis meses de vida da criança. Essa prática considerada precoce é bem comum, uma vez que muitas mulheres precisam voltar a trabalhar quatro meses após o parto”, lamenta a ginecologista. Outra dúvida comum
é o tempo da mamada. Entretanto, o indicado é que o bebê esgote totalmente uma mama e solte o bico sozinho. Só então a mãe deverá oferecer a outra mama e, se a criança recusar, é sinal de que está saciada. Em alguns casos, a falta de orientação adequada pode levar a intercorrências como ingurgitamento, fissuras e mastites, que prejudicam o aleitamento e provocam dor e desconforto nas mães lactantes.
A doutora Danielle Aparecida da Silva, coordenadora do Banco de Leite Humano do Instituto Nacional de Saúde da Mulher, da Criança e do Adolescente Fernandes Figueira da Fundação Oswaldo Cruz (IFF/Fiocruz), lembra que toda mulher com dúvidas ou sofrendo com o aleitamento pode buscar orientações junto às equipes dos bancos de leite humano. Estas unidades funcionam como casa de apoio à amamentação, com equipe de assistência desde a gestação e sempre que a mulher que amamenta necessitar. “Qualquer mulher que estiver em fase de lactação e quiser ser doadora também pode entrar em contato com o banco de leite mais próximo”, orienta. Outro tópico cercado de dúvidas e, muitas vezes, de culpa, é
Essas fórmulas com 2’-FL já são aprovadas por órgãos reguladores no Brasil (Agência Nacional de Vigilância Sanitária – Anvisa), na Europa (European Food Safety Authority – EFSA) e pela Food and Drug Administration (FDA) nos Estados Unidos. No entanto, o custo das fórmulas infantis com esse oligossacarídeo costuma ser mais alto do que as fórmulas tradicionais sem esse composto, principalmente porque o 2’-FL é produzido por biotecnologia – o que eleva o valor final.
O pesquisador relata que estudos mostram que o 2’-FL sintético tem efeitos comparáveis ao natural em vários aspectos, mas ainda não iguais ao conjunto completo do leite humano. Pesquisas clínicas com bebês alimentados com essas fórmulas mostram menor incidência de infecções respiratórias e gastrointestinais, respostas imunes mais próximas às de bebês amamentados e microbiota intestinal mais semelhante à dos lactentes que recebem leite materno. Em vários estudos de coorte e ensaios clínicos controlados, os efeitos do 2’-FL sintético também foram estatisticamente significativos. No entanto, o leite materno contém mais de 150 tipos de oligossacarídeos, enquanto a fórmula (mesmo com 2’-FL) possui apenas um ou dois. “Sendo assim, o 2’-FL sintético se mostra seguro, eficaz e ajuda a reduzir algumas diferenças entre fórmula e leite humano, mas o aleitamento materno ainda é insubstituível”, assegura.

o desmame, embora seja um processo que deve ser conduzido de forma respeitosa e partir da mãe ou do bebê. A orientação é alternar a amamentação com o alimento que vem sendo introduzido, aumentar o intervalo das mamadas e, aos poucos, fazer a transição de modo que não prejudique a criança. “Para a mãe, a introdução de outro alimento pode ser vista como um alívio, pois a amamentação demanda cerca de quatro horas por dia e não pode ser feita por outra pessoa. Por isso, sem apoio realmente fica muito difícil”, complementa a professora Eunice Francisca Martins.
O Brasil também mantém políticas públicas que protegem e promovem o aleitamento materno, como a licença-maternidade de 120 dias e licença-paternidade de sete dias. Além
O Ministério da Saúde, em parceria com instituições como a Universidade Federal do Rio de Janeiro (UFRJ) e a Fundação Oswaldo Cruz (Fiocruz), realizou o Estudo Nacional de Alimentação e Nutrição Infantil (ENANI) para obter um retrato atualizado da nutrição infantil no Brasil. O foco foi avaliar a prevalência dos indicadores de aleitamento materno, as práticas relacionadas e o uso de mamadeiras, chuquinhas e chupetas entre crianças menores de dois anos de idade. A primeira edição foi realizada em 2019 com 14.558 crianças menores de dois anos e mostrou que 96,2% foram amamentadas em algum momento, enquanto 62,4% foram amamentadas na primeira hora de vida. A prevalência do aleitamento materno exclusivo em menores de seis meses foi de 45,8%, com maior prevalência na região Sul. Já o aleitamento continuado no primeiro ano de vida entre crianças de 12 a 23 meses foi de 43,6%, sendo mais prevalente na região Nordeste. A duração mediana do aleitamento materno exclusivo foi de três meses. A enfermeira Eunice Francisca Martins afirma que, embora sejam números expressivos, ainda estão aquém do preconizado pela OMS. Além disso, a prática do aleitamento materno cruzado, apesar de ser contraindicada pelo Ministério da Saúde, apresentou frequência relativamente elevada (21,1%), sendo maior na região Norte. Das mães com bebês de menos de dois anos ouvidas, 4,8% doaram leite materno para os bancos de leite humano – número muito abaixo do esperado –, enquanto 3,6% das crianças nessa faixa etária receberam leite humano ordenhado pasteurizado desses bancos. O uso de mamadeiras ou chuquinhas entre as crianças com menos de dois anos de vida foi de 52,1%, sendo maior nas regiões Nordeste e Sul, enquanto a prevalência do uso de chupeta foi de 43,9%, com prevalência nas regiões Sul, Sudeste e Nordeste. “O uso desses artifícios para alimentar ou acalmar a criança pode prejudicar a continuidade do aleitamento materno. Os números evidenciam a necessidade do fortalecimento de ações, políticas e programas de promoção, proteção e apoio ao aleitamento materno”, enfatiza.

disso, a Iniciativa Hospital Amigo da Criança (IHAC) valoriza o aleitamento materno desde a primeira hora de vida. Já a Sala de Apoio à Mulher Trabalhadora que Amamenta estimula a criação de espaços nas empresas públicas ou privadas nos quais as lactantes podem amamentar ou coletar o leite com conforto, privacidade e segurança. “É fundamental que a sociedade compreenda a importância da amamentação para todos os envolvidos para que possamos ter uma população mais saudável no futuro”, acentua a doutora Danielle Aparecida da Silva. Para manter o controle da propaganda e venda de fórmulas e sucedâneos do leite humano foi criada, em 2006, a Norma Brasileira de Comercialização de Alimentos para Lactentes, Bicos, Mamadeiras e Chupetas (NBCAL), que estabelece regras para a promoção comercial, rotulagem e divulgação de alimentos e produtos de puericultura destinados a recém-nascidos e crianças de até três anos de idade. • danieLLe aPareCida da siLva

JÁ ESTÁ COMPROVADO
Adenilde Bringel
Estudos desenvolvidos sobre o leite materno conseguiram comprovar o que, empiricamente, a humanidade já sabia desde os tempos ancestrais: é um alimento completo para a saúde dos bebês. Entretanto, as técnicas de análise mais recentes também têm ajudado a mostrar quais são os principais componentes presentes nesse alimento e de que maneira agem no organismo dos bebês, garantindo a formação de uma microbiota equilibrada. Consequentemente, o bebê terá um sistema imune robusto que vai garantir a saúde e a proteção ao longo da vida. O aleitamento materno participa da formação da microbiota do bebê de diferentes maneiras. Uma delas é pela presença de prebióticos naturais – Oligossacarídeos do Leite Humano (OLH), do inglês Human Milk Oligosaccharides (HMO). Esses carboidratos complexos não digeríveis estimulam o crescimento de Bifidobacterium e de outras bactérias protetoras no intestino. Além disso, o leite contém microrganismos maternos, a exemplo de Staphylococcus, Streptococcus, Bifidobacterium e Lactobacillus. Por fim, o alimento possui fatores antimicrobianos como imunoglobulinas, lactoferrina e lisozima, que protegem os bebês contra infecções.
Os OLHs são estruturas complexas derivadas do alongamento de uma estrutura de lactose por resíduos de fucose
e/ou resíduos de ácido siálico, podendo haver diferentes tipos de ligação – o que confere uma diversidade de conformações possíveis. De acordo com a nutricionista Marina Padilha, do Observatório de Epidemiologia Nutricional da Universidade Federal do Rio de Janeiro (UFRJ), mais de 150 OLHs já foram descritos até o momento. “Esses oligossacarídeos não são digeridos pelo corpo humano e alimentam seletivamente as bactérias benéficas, principalmente aquelas pertencentes ao gênero Bifidobacterium, presentes no intestino do bebê”, detalha.
Ademais, o leite contém altos teores de anticorpos secretórios (IgA) produzidos na mucosa materna, que protegem o intestino do bebê e direcionam seu sistema imune a reconhecer antígenos sem desencadear inflamação excessiva. Portanto, além de fornecer bactérias benéficas para que se multipliquem no trato gastrointestinal do bebê, o leite materno contém antimicrobianos que dificultam a proliferação de bactérias nocivas. Em conjunto, estes fatores atuam para o estabelecimento de uma microbiota saudável e para proteção das crianças.
A microbiota do leite materno parece variar de acordo com dieta, paridade, geografia e parto (cesárea ou vaginal), o que pode explicar diferenças de saúde entre populações. Por esse motivo, a modulação da microbiota do leite por meio da dieta materna poderia representar uma estratégia inovadora para influenciar precocemente a colonização microbiana do bebê (leia quadro). A pesquisadora informa que, como o leite é a principal fonte de bactérias iniciais para o recém-nascido, alterar sua composição microbiana pode repercutir na saúde infantil. Assim, se a dieta da mãe pode aumentar microrganismos benéficos no leite, isso seria traduzido em maior resistência a infecções, menor risco de alergias e melhor desenvolvimento imu-

nológico no bebê. “Como o leite materno é um ecossistema dinâmico cujos componentes bioativos interagem de forma complexa com a microbiota do bebê, já é sabido que variantes genéticas maternas (como genes FUT2/FUT3) também alteram o perfil de OLHs e influenciam o estabelecimento de Bifidobacterium no intestino da criança”, ressalta.
HERANÇA MICROBIANA
Além de fornecer nutrientes perfei tamente balanceados, o leite materno contém imunoglobulinas, citocinas e células que conferem proteção imediata contra agentes infecciosos. Além disso, promove uma colonização intesti nal saudável reduzindo o risco de diarreias, infecções res piratórias e até condições crônicas na infância como alergias, sobrepeso e dia betes tipo 2. “Em suma, a amamentação fornece uma ‘herança microbia na’ materna e um coque tel imunológico único que promove equilíbrio intes tinal e desenvolvimento saudável. Esses aspectos reforçam que o leite ma terno é um alimento vivo


e insubstituível para a saúde da criança no curto e longo prazo”, enfatiza. A nutricionista Marina Padilha acrescenta que, embora as fórmulas infantis modernas tentem mimetizar o leite humano adicionando galactooligossacarídeos (GOS) e frutooligossacarídeos (FOS), ou mesmo alguns OLHs, ainda não reproduzem a diversidade completa de Oligossacarídeos do Leite Humano e fatores imunes presentes no leite materno.
Já o leite humano doado por meio dos bancos de leite passa por pasteurização antes de ser oferecido ao recém-nascido, processo que visa oferecer um alimento seguro do ponto de vista microbiológico. “Porém, a pasteurização elimina tanto as
bactérias nocivas quanto a maior parte das bactérias vivas, ou seja, as bactérias naturais do leite são destruídas”, informa. Além disso, reduz significativamente algumas proteínas imunológicas, em particular as concentrações de IgA secretória, lactoferrina e lisozima. Por outro lado, fatores não proteicos como os oligossacarídeos (prebióticos) perma-
O estudo ‘Dieta com prebióticos pode modular a microbiota do leite materno’, desenvolvido em 2020 durante o doutorado da nutricionista Marina Padilha no Centro de Pesquisa em Alimentos (Food Research Center – FoRC) da Faculdade de Ciências Farmacêuticas da Universidade de São Paulo (FCF-USP), tinha como principal objetivo avaliar se a modulação da dieta da mãe com um prebiótico (FOS) influenciaria a composição microbiana do leite materno – um conceito pouco explorado até então. A pesquisa foi realizada em parceria com a Universidade de Copenhagen, na Dinamarca, com orientação da professora doutora Susana Saad, da FoRC/FCF-USP. O resultado confirmou que a modulação via prebióticos é factível. No entanto, ainda são necessários espopulacionais para identificar outros fatores que interferem nessa modulação. O grupo de pesquisa também buscava saber se a suplementação dietética da mãe poderia alterar positivamente o microbioma do leite, abrindo caminho para melhorar a saúde dos lactentes por meio da nutrição
necem intactos, em grande parte, após o aquecimento. Sendo assim, o leite doado continua a fornecer muitos nutrientes e prebióticos naturais ao bebê – superando as fórmulas infantis –, embora ofereça menos proteção imunológica do que o leite materno cru devido à perda dos microrganismos vivos e de parte das proteínas de defesa.


“Sabendo que o leite é uma via importante de transferência de bactérias maternas ao bebê, queríamos avaliar se essa via de comunicação mãe-filho poderia ser manipulada nutricionalmente”,
afirma a nutricionista, primeira autora da pesquisa. O FOS foi escolhido porque são prebióticos estabelecidos, amplamente estudados na população e conhecidos por estimular bactérias benéficas, como bifidobactérias, no intestino. Estes compostos não digeríveis também servem de substrato para microrganismos protetores. Para o estudo, o grupo usou maltodextrina como placebo/inoculante inerte – que não fornece efeitos prebióticos por ser um carboidrato facilmente digerível e sem efeito bifidogênico. O ensaio clínico randomizado incluiu 53 mulheres que amamentavam seus bebês de maneira exclusiva. Destas, 28 receberam 4,5g/dia de FOS + 2g de maltodextrina e 25 receberam 2g/dia de maltodextrina (placebo), durante 20 dias. Amostras de leite foram coletadas antes e após a intervenção, e os pesquisadores sequenciaram o gene 16S rRNA para caracterizar a microbiota.
O resultado mostrou que não houve alterações estatisticamente significativas na diversidade ou nas abundâncias relativas dos principais gêneros bacterianos, ou seja, o leite coletado dos grupos FOS e placebo permaneceram semelhantes após a intervenção. “Entretanto, ao analisar as mudanças globais na comunidade microbiana, o grupo que recebeu FOS apresentou trajetórias de microbiota significativamente maiores, indicando maior variação na microbiota do leite”, relata a autora da pesquisa. Outro achado-chave foi que a idade materna influenciou essa resposta. Assim, as mães mais jovens sofreram mudanças mais acentuadas com FOS, enquanto as mais velhas responderam de forma semelhante ao controle. De acordo com a pesquisadora, o resultado mais relevante foi que o FOS induziu alterações estatisticamente significativas na composição microbiana do leite, embora as taxas de aumento de bactérias específicas como Bifidobacterium não tenham mudado. Portanto, os resultados sugerem que é possível manipular a microbiota do leite materno pela dieta, com resposta dependente de fatores individuais.
O estudo observacional ‘The human milk microbiota is modulated by maternal diet’, com par ticipação da pesquisadora Marina Padilha e da professora doutora Carla Taddei, do Laboratório de Microbioma Humano do Instituto de Ciências Biomédicas da Universidade de São Paulo (ICB-USP), analisou amostras de 94 mulheres brasileiras. As análises identificaram três gêneros presentes em todas as amostras – Streptococcus, Staphylococcus e Corynebacterium. Além disso, 10 gêneros estavam presentes em pelo menos 90% das amostras, que eram Veillonella, Rubrobacter, Pseudomonas, Halomonas, Trabulsiella, Chelonobacter, Acinetobacter , Actinomyces, Rothia e Lactobacillus. Já a Bifidobacterium esteve presente em 78% das amostras e em proporção média de 1%. “Ao explorar os resultados, identificamos dois perfis ( clusters ) de microbiota de leite materno. Um cluster marcado pela predominância de Staphylococcus e outro por Streptococcus”, relata a nutricionista Marina Padilha. Ambos os gêneros bacterianos foram encontrados em 100% das amostras e o que mudava era apenas a proporção entre ambos nas mulheres avaliadas.
Neste estudo, foi identificado que a ingestão materna de vitamina C, pectina e licopeno durante a gestação estava associada aos clusters de leite materno, sendo que a ingestão destes nutrientes foi maior no cluster com predominância de Staphylococcus. A nutricionista Marina Padilha ressalta que, por se tratar de um estudo observacional, não é possível fazer suposições de causa e efeito. Entretanto, os resultados podem guiar os pesquisadores para que prossigam com as investigações. “Investigar a microbiota materna antes e após a intervenção com o prebiótico complementaria o meu estudo inicial no sentido de avaliar se mudanças na microbiota intestinal da mãe explicariam mudanças na microbiota do leite. Gostaríamos de verificar se certas bactérias intestinais migraram para o leite via eixo intestino-mama”, adianta.
mia e da modulação da função microbiana. O Germina é uma coorte prospectiva contínua projetada para avaliar as díades mãe-bebê nos primeiros 1.000 dias de vida.
De acordo com a pesquisadora Carla Taddei, coordenadora dos estudos, esse é o primeiro trabalho do Brasil que descreve a microbiota de crianças entre 3 e 36 meses de idade em número expressivo por meio da técnica de Shotgun, que permite uma análise muito mais profunda do que a metodologia do sequenciamento do gene 16S. “Na metodologia do 16S conseguimos sequenciar, por amostra, de 500 a 600 mil leituras de DNA, enquanto o Shotgun sequenciou 5 milhões de sequências por amostra”, compara. Assim, essa profundidade de sequenciamento permite que o grupo consiga ir mais fundo nos resultados e possa fazer as análises das rotas metabólicas para investigar quais são os genes que essas bactérias têm e o que estão fazendo com a microbiota.

Embora a literatura tenha afirmado, até pouco tempo, que o tipo de parto é um preditor da microbiota devido à primeira carga bacteriana que a criança recebe, estudos mais recentes mostram que é a amamentação que modula essa microbiota. Portanto, se sobrepõe ao parto em importância. Além disso, é consenso que a amamentação exclusiva (EBF, na sigla em inglês) desempenha um papel crucial na montagem e no desenvolvimento do microbioma intestinal infantil. No entanto, poucos estudos investigaram os efeitos da EBF na restauração de um microbioma perturbado. Por isso, pesquisadores do Laboratório de Microbioma Humano do ICB-USP utilizaram sequenciamento metagenômico para avaliar a montagem do microbioma intestinal de 525 bebês brasileiros de 3 a 9 meses, participantes do Projeto Germina. Assim, foi possível demonstrar os primeiros determinantes da taxono-
A análise das amostras de crianças de 3 a 9 meses mostrou que a amamentação exclusiva altera a abundância relativa de genes relacionados à taxonomia e à função do microbioma, com efeitos que variam com o modo de entrega. Por exemplo, a EBF altera o padrão de carboidratos, o metabolismo lipídico e as vias de estrutura celular. Além disso, a idade do microbioma está mais próxima da idade cronológica infantil em bebês com aleitamento exclusivo (em relação a bebês não EBF), o que significa um menor índice de maturação do microbioma intestinal – o que é esperado para esta idade. “Usando uma abordagem complementar de aprendizado de máquina, mostramos que Escherichia coli, Ruminococcus gnavus e Clostridium neonatale, bem como as vias de vitamina K e antígeno O, contribuem fortemente para a previsão da EBF”, relata a professora Carla Taddei. Os resultados
mostraram, ainda, que Escherichia coli e Bifidobacterium longum eram as espécies dominantes até os sete meses da criança, independentemente das práticas de amamentação e do modo de parto. Em momentos anteriores avaliados, Bacteroides vulgatus, Bacteroides fragilis, Bifidobacterium breve, Bifidobacterium bifidum e Ruminococcus gnavus estavam consistentemente entre as espécies mais abundantes, ao lado de C. neonatale em bebês de três meses, e de Veillonella parvula em bebês de 5 a 7 meses. Aos 8 a 9 meses, B. longum e B. fragilis permaneceram as espécies mais abundantes, seguidas por B. vulgatus, B. breve, R. gnavus, E. coli e Prevotella copri. Os resultados do estudo ‘Exclusive breastfeeding is associated with the gut microbiome maturation in infants according to delivery mode’ mostram, ainda, que a amamentação exclusiva também influencia na maturação do microbioma no início da vida. Além das amostras de fezes dos bebês, o grupo colheu amostras do leite das mães para avaliar a relação das bactérias encontradas em ambos. “Existe um mundo de bactérias no leite

e não sabemos nem um terço do que estão fazendo ali. A literatura diz que a microbiota sofre uma sucessão bacteriana importante ao longo do primeiro ano de vida da criança. Mas, com três meses de vida, os bebês já têm uma população de bactérias relativamente estável”, afirma a professora Carla Taddei.
Os resultados também confirmaram que a microbiota dos bebês é dominada por Bifidobacterium, principal degradadora do oligossacarídeo do leite materno. A Bifidobacterium quebra e disponibiliza metabólitos para outras bactérias e, assim, regula a microbiota. No estudo, essa dominância foi vista aos 3 e 6 meses de idade. Em segundo lugar vem a Escherichia coli, conhecida na literatura como uma bactéria patobionte ou até potencialmente patogênica – mas que é considerada normal na população do Brasil. Neste estudo, essa bactéria foi associada com produção de vitamina K, modulada pela amamentação exclusiva. “Tudo isso é muito incrível, porque a microbiota do bebê é dominada por E. coli e

Bifidobacterium. E, em contrapartida, a microbiota do leite da mãe é dominada por Staphylococcus e Streptococcus, que estão ali fazendo alguma coisa importante que não é colonizar o intestino do bebê”, descreve a professora. Por esse motivo, os pesquisadores querem desvendar qual é o papel dessas duas bactérias no leite materno. Além disso, procuram encontrar a correlação com alguma rota metabólica que consiga explicar esse antagonismo.
Embora ainda restem muitas dúvidas a respeito dos caminhos que Bifidobacterium e Lactobacillus percorrem para sair do intestino da mãe e chegar à glândula mamária, a literatura já aponta três vias possíveis. A primeira é a via enteromamária, com células dendríticas intestinais da mãe captando essas bactérias e carreando até a mama. “Ainda não sabemos como essas bactérias percorrem esse caminho, se é mesmo apenas pelas células dendríticas ou via sistema imune, macrófagos ou fagócitos. O fato é que a glândula mamária e o leite têm muitas células imunológicas”, afirma a professora Carla Taddei. Também é consenso científico que a microbiota intestinal está diretamente relacionada à maturação do sistema imunológico, uma vez que essas bactérias interagem com o sistema imune e o ‘ensinam’ a diferenciar entre microrganismos benéficos e nocivos. A segunda via é a pele da mãe, porque o ducto mamário está exposto. E a terceira via é a boca do próprio bebê, dominada por Streptococcus. Assim, na hora em que ocorre a ‘pega’, pode acontecer um movimento retrógrado das bactérias da boca do bebê colonizando a glândula mamária.
As análises também mostraram a trajetória da formação da microbiota, ou seja, o índice de maturação ao longo do tempo. Ao nascer, o bebê tem uma colonização por anaeróbios facultativos dominantes, organismos que podem sobreviver tanto na presença como na ausência de oxigênio e que consomem o oxigênio do intestino e vão tornando o ambiente anaeróbio. A partir daí, começa a colonização por bactérias anaeróbias e um aumento gradativo da diversidade para permitir a tolerância imunológica. De acordo com a professora, quanto mais lento for o aumento da diversidade no primeiro ano de vida, melhor para a criança e para o sistema imune. “E ter a Bifidobacterium como dominante é ótimo, porque essa bactéria quebra o oligossacarídeo do leite e alimenta as outras bactérias em cross-feeding, que é a alimentação cruzada, deixando o ambiente estável. Quando a criança chega aos seis meses de idade e começa a receber a dieta sólida no lugar do aleitamento exclusivo, essa microbiota já está devidamente preparada”, detalha. E, neste sentido, não importa o tipo de parto, mas sim a amamentação exclusiva. •
Mira Andini1,3, Etika Ratna Noer1, Martha Irene Kartasurya2, Kusmiyati Tjahjono1, Adriyan Pramono1
1Department of Nutrition Science, Faculty of Medicine, Diponegoro University, Indonesia – 2Department of Public Health Nutrition, Faculty of Public Health, Diponegoro University, Indonesia –3Nutrition Department, Health Polytechnic Makassar, Indonesia
Aobesidade é caracterizada pelo acúmulo excessivo de gordura decorrente de um desequilíbrio entre a ingestão e o gasto energético ao longo do tempo. A condição tornou-se um problema global devido ao aumento de prevalência todos os anos, tanto em países desenvolvidos quanto em desenvolvimento. A Pesquisa Básica de Saúde (Riskesdas) de 2018, por exemplo, revelou que a prevalência de obesidade em adultos na Indonésia aumentou de 14,8% em 2013 para 21,8% em 2018. A obesidade foi mais prevalente entre mulheres (29,3%) do que entre homens (14,5%). A maior prevalência na população adulta da cidade de Makassar foi de 24,05%. Uma das principais causas da obesidade são o consumo excessivo de alimentos e a baixa atividade física. A proporção de inatividade física na cidade de Makassar foi de 31,92%. A proporção de hábitos de consumo alimentar de gordura/colesterol da população ≥ 1 vez por dia na cidade de Makassar foi de 35,5%. Também foi registrado que 13,3% da população não consumia vegetais e frutas diariamente, em uma semana, na cidade.

Desequilíbrios de micronutrientes também contribuem significativamente para a obesidade, mas o balanço energético positivo demonstrou ser o principal fator contribuinte. Pessoas com sobrepeso ou obesas têm maior probabilidade de desenvolver deficiências de micronutrientes ao consumir quantidades excessivas de energia, do que aquelas com peso normal. Indivíduos obesos também podem apresentar baixas concentrações séricas de zinco porque estão sob estresse oxidativo crônico, o que aumenta a síntese de glicocorticoides e diminui os transportadores de zinco. Além disso, as citocinas secretadas pelo tecido adiposo podem aumentar a expressão do transportador de zinco, alterando a distribuição desse mineral no corpo. O zinco é um oligoelemento que atua como cofator de inúmeras enzimas e como antioxidante com propriedades antiinflamatórias, proporcionando benefícios à saúde em diversas áreas do metabolismo. Assim, o metabolismo lipídico é significativamente influenciado pelo zinco. Segundo os resultados de alguns ensaios clínicos ou meta-análises, a suplementação com zinco demonstrou melhorar diversos perfis lipídicos. Entretanto, vários estudos não corroboraram essa conclusão. Além de ser uma causa de obesidade e sobrepeso, a deficiência de zinco é um efeito colateral do sobrepeso. Por exemplo, a hipozincemia deteriora a saúde imunológica, oxidativa e metabólica relacionada à obesidade. De acordo com Syane et al., aumentar a ingestão de zinco por meio de alimentos e/ou suplementação pode ser uma tática prática para amenizar problemas ou sintomas relacionados à obesidade.
Acredita-se que os probióticos desempenhem um papel adicional na fisiopatologia da obesidade. Tem sido investigado como os probióticos, particularmente Lactobacillus e Bifidobacterium, podem equilibrar a microbiota intestinal e
Este ensaio clínico randomizado, duplocego e controlado por placebo foi realizado com 84 mulheres obesas saudáveis. Os critérios de inclusão foram idade de 30 a 50 anos, não fumante, IMC > 25 (Kg/m²) e disposição para restrição calórica de 500kcal. Os critérios de exclusão incluíram gravidez, amamentação e pós-menopausa. Aquelas que consumiam suplementos de zinco e Lactobacillus casei durante os três meses anteriores não foram incluídas, bem como as que utilizavam medicamentos que podem interagir com os perfis lipídicos séricos e a perda de peso. As participantes forneceram
permissão por escrito após serem informadas sobre o propósito do estudo. Utilizando uma técnica de bloco aleatório gerada pelo Random Allocation Software (RAS), as participantes elegíveis foram randomizadas aleatoriamente para grupos de intervenção-placebo. Com base em dados do mesmo estudo, o tamanho da amostra foi estabelecido. O nível de confiança foi estabelecido em 95% e a fórmula N = [(Z1-α/2 + Z1-B) 2 (DP12 + DP22)] /Δ2 foi usada para calcular as 21 amostras em cada grupo (considerando uma taxa de abandono de 40%). Durante um mês, o
grupo Zinco (n=21) recebeu um comprimido de 30mg de gluconato de zinco por dia. As dosagens foram selecionadas com base em estudos anteriores. O grupo Lactobacillus casei (LcS) (n=21) recebeu 6,5x109 UFC/ dia, o grupo de cossuplementação recebeu um comprimido de gluconato de zinco e 6,5x10 9 UFC de Lactobacillus casei por dia, enquanto o grupo placebo (n=21) não recebeu nada. Todos os participantes do estudo, exceto o grupo placebo, foram instruídos a limitar a ingestão calórica regular a 500kcal para garantir que seguiriam todas as instruções.
tratar a obesidade a fim de melhor compreender como afetam a disbiose intestinal. A indução/ proteção contra a endotoxemia metabólica, a modulação do metabolismo dos ácidos biliares e a síntese de ácidos graxos de cadeia curta (AGCC) são as três principais maneiras pelas quais o equilíbrio da microbiota intestinal pode modular o peso corporal. Além disso, o amido, os açúcares não absorvidos, os polissacarídeos celulósicos e não celulósicos e as mucinas – que têm um impacto direto no metabolismo lipídico e na produção de energia – fermentam para formar AGCC. De modo geral, a microbiota intestinal pode impactar o equilíbrio energético, uma vez que também regula a capacidade do intestino de absorver nutrientes. Dessa forma, zinco e Lactobacillus podem ser usados em mulheres obesas para aumentar a resistência do corpo aos radicais livres.
O probiótico Lactobacillus casei Shirota é uma bactéria lática que proporciona o benefício de fortalecer o sistema imunológico, atuando como antioxidante e reduzindo os níveis de colesterol. O mecanismo de redução do colesterol pode ocorrer porque o ácido lático presente nas bebidas probióticas pode degradar o colesterol em coprostanol – uma substância que não pode ser absorvida pelo intestino. Graças ao Lactobacillus, o coprostanol e o colesterol restante podem ser excretados pelas fezes. Em outras palavras, a quantidade de colesterol

Amostras de sangue foram obtidas no início e no final do estudo, enquanto as mulheres estavam em jejum por 12 horas. Dados demográficos foram coletados por meio de pesquisas. Sem sapatos e com o mínimo de roupas, o peso corporal e a porcentagem de gordura corporal foram determinados usando um dispositivo de análise de impedância bioelétrica (BIA) (TANITA BC-542). Um estadiômetro (Seca) também foi usado para medir a altura sem sapatos. O peso (em quilos) dividido pela altura (em metros quadrados) produziu o IMC. Um estadiômetro (Onemed) foi usado
absorvida pelo corpo é baixa. Um relatório sobre o assunto explica que a redução do colesterol por bactérias do ácido láctico (Lactobacillus) pode chegar a 27%-38%. Estudos anteriores descrevem os efeitos positivos da suplementação com probióticos, ou seja, a redução do Índice de Massa Corporal (IMC), da gordura corporal total e de marcadores de distúrbios metabólicos. Ademais, ocorre um aumento do número de microrganismos intestinais benéficos e níveis mais elevados de ácidos graxos de cadeia curta.
Os efeitos dos probióticos e do zinco no trato gastrointestinal são semelhantes, principalmente os efeitos imunomoduladores. O zinco possui outros efeitos, como a proteção contra germes patogênicos e a manutenção da integridade da barreira. Além disso, este mineral afeta a regeneração e a função das vilosidades intestinais, o que afetará a formação de enzimas dissacaridases como lactase, sacarose e maltase, que afetam o transporte de sódio (Na) e glicose. Por um lado, os resultados do efeito do Lactobacillus casei ou zinco foram inconsistentes em estudos anteriores. Por outro lado, não houve nenhum ensaio clínico para avaliar o efeito da cossuplementação de zinco e Lactobacillus casei nos perfis lipídicos em pacientes obesos. O presente ensaio clínico de fase 2, randomizado, duplo-cego e controlado por placebo, com múltiplos braços e grupos paralelos, teve como objetivo avaliar o efeito da suplementação de zinco e Lactobacillus casei, juntamente com uma dieta para perda de peso, nos perfis lipídicos séricos de triglicerídeos (TG), colesterol total (CT), colesterol de lipoproteína de alta densidade (HDL-C) e colesterol de lipoproteína de baixa densidade (LDL-C), circunferência da cintura e percentual de gordura corporal em mulheres saudáveis com sobrepeso ou obesas.
para medir a circunferência da cintura (CC). Usando o Thermo ScientificTM IndikoTM plus Clinical Chemistry Analyzer, foram medidas as concentrações séricas de TG, CT, HDL-C e LDL-C.
Todas as análises foram realizadas usando um pacote de software estatístico (SPSS), versão 22.0 (SPSS, Inc). A significância estatística foi determinada em p<0,05. A distribuição normal e a homogeneidade das variâncias para variáveis quantitativas foram verificadas pelo teste de Kolmogorov-Smirnov e testes de Leven, respectivamente. Os dados foram relatados
como média ± desvio padrão (DP) e mediana (intervalo interquartil) para dados normalmente e não normalmente distribuídos, respectivamente. As comparações dentro do grupo foram realizadas usando um teste t para amostras pareadas. As comparações para as variáveis foram realizadas usando uma ANOVA unidirecional e KruskalWallis para dados normalmente e não normalmente distribuídos, respectivamente. Mudanças (pré/pós-intervenção) foram calculadas com base na diferença das variáveis da linha de base (pré-intervenção) até o final (pós-intervenção) do estudo.
Embora o limite tolerado para a ingestão máxima de zinco (40mg/dia) tenha sido menor do que nesta investigação, o uso de 30mg/dia foi superior à quantidade recomendada (IDRs de 8 a 11mg/dia). Apesar das diretrizes de estilo de vida, da dieta hipocalórica e do acompanhamento contínuo dos participantes, não houve diferença significativa na ingestão alimentar entre os grupos. A redução média na ingestão calórica em cada grupo foi de aproximadamente 500kcal (valores sugeridos). Entre os períodos pré e pós-intervenção houve uma mudança no peso e no IMC em direção à melhora. Consequentemente, isso pode ser resultado dos efeitos benéficos dos suplementos no peso e no IMC.
Estudos anteriores demonstraram que a suplementação de zinco melhora diversos níveis de lipídios no sangue (CT, HDL, LDL e TG) em diversas populações. Adicionalmente, os resultados de uma meta-análise realizada por Asbaghi et al. demonstraram os efeitos positivos da suplementação de zinco sobre o HDL em ambos os estudos, com duração igual ou superior a 12 semanas. Além disso, apenas estudos com duração igual ou superior a 12 semanas demonstraram redução nos níveis de TG, CT e LDL no sangue após a administração de zin-
afetando a expressão do transportador; (2) pode aumentar a sensibilidade à insulina ou a resistência à insulina, fosforilando substratos do receptor de insulina nos adipócitos; (3) pode inibir a lipólise nos tecidos adiposos, o que reduz a quantidade de ácidos graxos liberados e, em última análise, regula a síntese de lipoproteínas (secreção hepática de VLDL e LDL) do fígado; (4) pode influenciar a expressão gênica de enzimas envolvidas na homeostase lipídica hepática que, por sua vez, regula a síntese e a utilização de lipídios nas mitocôndrias e nos peroxissomos.
Suplementos probióticos demonstraram reduzir o peso corporal, o IMC e o percentual de gordura. Os probióticos também têm a capacidade de se ligar ao colesterol para diminuir a absorção intestinal. Os probióticos podem diminuir, ainda, a quantidade de sais biliares que circulam pelo sistema entero-hepático,
o que forçaria o fígado a ressintetizar sais biliares, mobilizando mais colesterol. Isso reduziria os níveis de colesterol. Atualmente, são conhecidos dois mecanismos distintos pelos quais os microrganismos intestinais controlam os níveis de lipídios no sangue. Uma maneira é controlar o metabolismo dos ácidos biliares, que influencia outros processos metabólicos e modifica os níveis de lipídios no sangue.
Os probióticos também podem influenciar os índices antropométricos e a composição corporal por meio de vários mecanismos, incluindo redução do tamanho dos adipócitos, aumentando a oxidação de ácidos graxos e diminuindo a absorção de lipídios; inibição da adipogênese, produzindo ácido linoleico conjugado (CLA); aumento da secreção do peptídeo semelhante ao glucagon-1 (GLP-1) e do peptídeo YY (PYY), indutores de saciedade; aumento da sacie-
A riqueza ou a diversidade e abundância de espécies microbianas encontradas no intestino é uma característica crucial da microbiota intestinal, que tem sido objeto de extensa investigação. Estudos que demonstram que pessoas com sobrepeso ou obesas normalmente apresentam um microbioma intestinal menos diversificado do que aquelas com peso corporal saudável contribuíram para o crescente conjunto de dados que relacionam a riqueza microbiana intestinal à obesidade. Além disso, uma maior diversidade de bactérias intestinais tem sido associada a melhores resultados de saúde, enquanto uma diversidade reduzida tem sido associada a uma série de doenças, incluindo a obesidade. Pesquisas demonstraram que a microbiota intestinal de pessoas obesas normalmente exibe menor diversidade alfa, sugerindo uma população microbiana menos variada e bem equilibrada. Acredita-se que esse desequilíbrio na microbiota intestinal influencie a regulação da fome, o metabolismo energético e a inflamação – todos os fatores que desempenham um papel no desenvolvimento da obesidade. Quando administrados por oito semanas a pessoas com alto índice de massa corporal, Lactobacillus acidophilus, Lactobacillus casei e Bifidobacterium lactis reduziram os indicadores inflamatórios e o percentual de gordura corporal. Esses resultados sugerem que os probióticos podem reduzir a inflamação e melhorar uma série de fatores relacionados à saúde. Assim, perder peso por meio da dieta pode melhorar o metabolismo do hospedeiro e reduzir a chance de comorbidades potenciais relacionadas à obesidade. As descobertas sobre os efeitos da perda de peso dietética na composição e função do microbioma em ensaios randomizados têm sido ambíguas, apesar de as evidências sugerirem que esses benefícios são devidos a modulações do microbioma intestinal e a metabólitos relacionados, mediante restrição calórica. Amostras pequenas, curtas durações dos ensaios e uma variedade de metodologias de avaliação do microbioma empregadas

dade por meio do aumento da síntese de ácidos graxos poli-insaturados de cadeia curta; e modulação da expressão do fator adiposo induzido pelo jejum (FIAF), que parece promover a lipólise do tecido adiposo e, subsequentemente, o redirecionamento dos lipídios do armazenamento para a circulação. A fermentação bacteriana produz AGCC que incluem acetato, butirato e propionato. Esses compostos servem como substratos energéticos e como reguladores do apetite e da saciedade. Ao ativar os receptores acoplados à proteína G, GPR41 e GPR43 nas células epiteliais intestinais, os AGCC também desempenham um papel na regulação do metabolismo energético e da sensibilidade à insulina em órgãos periféricos.
MEDIDAS ANTROPOMÉTRICAS
Após a intervenção houve uma redução significativa nas medidas antro-
pométricas de circunferência da cintura e nos índices de porcentagem de gordura corporal. Numerosos estudos também demonstraram que cepas bacterianas específicas, como Lactobacillus e Bifidobacterium spp., podem reduzir o IMC, a circunferência da cintura e a porcentagem de gordura corporal quando combinadas com prebióticos. De acordo com a pesquisa de Minami et al., adultos pré-obesos poderiam reduzir efetivamente a gordura corporal com o auxílio da cepa probiótica Bifidobacterium breve B-3. O estudo mostrou que a massa de gordura corporal e a porcentagem de gordura corporal dos participantes diminuíram significativamente após 12 semanas de tratamento. Além disso, uma investigação anterior ilustrou a capacidade de o Lactobacillus gasseri BNR17 diminuir a circunferência da cintura e a formação de gordura visceral em indivíduos com obesidade.
em pesquisas anteriores podem ser os responsáveis por isso, bem como as estratégias alimentares extremas e restritivas empregadas em numerosos ensaios de intervenção para induzir a perda de peso. Além disso, há uma diferenciação entre breves flutuações na composição do microbioma intestinal. Também tem sido difícil discernir mudanças associadas à intervenção, uma vez que a maioria das pesquisas anteriores não incluiu levantamentos recorrentes da microbiota intestinal.
Ademais, não está claro como as mudanças de longo prazo na composição do microbioma intestinal após a perda de peso durarão e o quanto estão relacionadas a mudanças nos metabólitos circulantes, indicadores antropométricos e clínicos, assim como à composição corporal. De acordo com os resultados do estudo, mulheres adultas obesas que receberam zinco e Lactobacillus casei por um mês apresentaram redução na circunferência da cintura, no percentual de gordura e nos perfis lipídicos séricos em comparação com um placebo. Dessa forma, o estudo pode ser útil na prevenção de pro blemas macrovasculares e microvasculares. No entanto, houve algumas desvantagens, como o breve período de acompanhamento.
Pesquisas futuras podem considerar a extensão da duração da intervenção e a determinação da segurança e eficácia das dosagens de suplementação de zinco e Lactobacillus casei. Até onde sabemos, este foi o primeiro estudo na área a analisar o impacto da cossuplementação com probióticos e zinco em mulheres adultas obesas, o que pode ser considerado o ponto forte do estudo. O artigo ‘Effects of zinc and co supplementation on lipid profile, waist circumstance, and body fat percentage in obesity women’ foi publicado no Journal of Medical Pharmaceutical and allied Sciences 13 – Issue 3, 6403, May – June 2024, Pages 6608-6616 – doi: 10.55522/jmpas. V13I3.6403. •

Um total de 84 participantes completou os 30 dias do estudo. Ninguém perdeu o acompanhamento. Não foram encontradas diferenças significativas entre os quatro grupos no início do estudo em relação às características gerais e clínicas dos participantes. Sobre a ingestão alimentar, os participantes de ambos os grupos consumiram um pouco menos do que a meta prescrita. Não houve diferença na ingestão energética entre os grupos. Os perfis lipídicos séricos pós-intervenção dos grupos zinco, LcS e ‘zinco e LcS’ apresentaram melhora significativa. Sobre a comparação da circunferência da cintura e da porcentagem de gordura corporal (%) dentro dos grupos, os indicadores antropométricos, nos quatro grupos, revelaram uma melhora significativa em relação ao pós-grupo. Assim, o estudo concluiu que nos grupos zinco, LcS e ‘zinco e LcS’ foram observadas diferenças significativas entre os períodos pré e pós-intervenção nos níveis séricos de CT, LDL, HDL e TG (p<0,05). Em relação à circunferência da cintura e ao percentual de gordura corporal, todos os grupos apresentaram diferenças significativas entre os períodos pré e pós-intervenção nos níveis séricos de CT e TG (p<0,05). Os efeitos benéficos da cossuplementação com ‘zinco e LcS’ foram relatados para as alterações em alguns perfis lipídicos (CT, LDL, HDL, TG), IMC, peso,

Adenilde Bringel
Com bactérias cada vez mais resistentes a antibióticos, os pesquisadores do Centro de Pesquisa em Biologia de Bactérias e Bacteriófagos do Estado de São Paulo (CEPID B3), sediado no Instituto de Química da Universidade de São Paulo (IQ-USP), procuram entender como esses microrganismos vivem, se relacionam e se replicam esmiuçando desde suas vias metabólicas até o modo como expressam seus genes. Além disso, parte do grupo se concentra nos estudos com vírus bacteriófagos, que são inimigos mortais de bactérias e já estão sendo usados pela Medicina, em alguns países, para tratar casos de resistência bacteriana. O professor doutor Shaker Chuck Farah, diretor do CEPID B3 e vice-diretor do Instituto de Química da USP, explica a importância desses estudos, quais resultados já foram alcançados nos diversos experimentos envolvendo bactérias e bacteriófagos e porque essas pesquisas são tão importantes para combater a resistência aos antimicrobianos e auxiliar no controle de infecções.
Já é possível afirmar como as bactérias vivem, se relacionam e replicam? Essa investigação é bem antiga. Bactérias são conhecidas há séculos e foram observadas com o uso dos primeiros microscópios no século XVII. Portanto, o crescimento bacteriano vem sendo estudado desde então. O estudo das bactérias também contribuiu muito para o nosso entendimento sobre a genética e a natureza do material genético. Os primeiros estudos sobre a natureza do gene, a relação entre um gene e uma atividade enzimática, ou seja, como um gene codifica uma enzima, foram feitos com bactérias e com bacteriófagos – que são os vírus que infectam as bactérias. Assim, sabemos muito sobre como as bactérias funcionam no nível molecular e sobre sua genética. A maior parte do conhecimento vem de algumas bactérias que foram estudadas com muita profundidade, mas existem literalmente bilhões de espécies bacterianas das quais, da grande maioria, não sabemos nada. Portanto, ainda temos muito a aprender sobre o comportamento das bactérias e como interagem com o ambiente e com seus hospedeiros. Às vezes, essas relações com os hospedeiros podem ser benéficas, mas também podem ser patogênicas e causar doenças, tanto em seres humanos quanto em animais e plantas.
Quais os mecanismos pelos quais bactérias podem adquirir novos genes? Bactérias podem adquirir genes por vários mecanismos diferentes. Por exemplo, podem sofrer mutações, e essas mutações estão acontecendo o tempo todo no DNA
das bactérias e também no DNA humano. Essas mutações geram novas versões de genes e podem ser muito simples, por exemplo, a troca de uma letra no código genético que modifica um pouquinho o gene para que desempenhe sua função de maneira um pouco diferente, mas também pode ser uma deleção ou uma inserção de algumas letras do DNA. Ou mesmo, pode ser uma deleção de um pedaço grande do DNA e até um deslocamento de um pedaço do DNA de uma região do cromossomo para outra. E esse deslocamento gera novas combinações da sequência do DNA, que gera novos genes. Esse é um jeito mais trivial de criar novos genes, mas tem outras maneiras em que bactérias em particular – mas também qualquer célula – pode adquirir DNA do meio externo.
O que ocorre se esse DNA entra em uma célula, por exemplo?
A célula tem enzimas que catalisam a inserção do DNA dentro dos cromossomos. E se esse DNA externo codifica uma proteína com função nova, ela vai ser incorporada dentro do genoma e este será um novo gene. Tem algumas bactérias que são muito eficientes em simplesmente adquirir DNA do meio externo – e tem muito DNA no meio externo. Todas as células que morrem podem ser tanto células bacterianas quanto células vegetais em decomposição, por exemplo, e aquele DNA que estava dentro da célula, agora, está do lado de fora. Esses pedaços de DNA estão no meio ambiente, em termos gerais. Assim, as bactérias podem pegar pedaços desse
DNA e incorporar dentro do seu genoma. Na grande maioria das vezes, isso não significa nada. Mas, de vez em quando, um pedaço desse DNA codifica algum gene com alguma função que é benéfica para a sobrevivência da bactéria. E ela pode sobreviver. Mas, além disso, tem maneiras em que bactérias trocam pedaços de DNA.
Como essa troca acontece?
Quando uma bactéria encosta com outra bactéria, muitas vezes, gera algum canal que é utilizado para transferir DNA de uma para a outra. Esse processo é chamado de conjugação. É como um ‘sexo bacteriano’. Sempre pensamos que bactérias se reproduzem de maneira assexuada, simplesmente dividindo e replicando o seu DNA. Mas espécies diferentes de bactérias também podem trocar pedaços de DNA. Muitas vezes, esses pedaços de DNA têm a forma de um círculo – são chamados de plasmídeos. E esses círculos de DNA podem codificar vários genes, inclusive genes que dão resistência contra antibióticos. Quer dizer, normalmente, esse plasmídeo de DNA codifica algo que dá algum tipo de vantagem para a bactéria. Por exemplo, pode dar uma vantagem para utilizar um nutriente ambiental para sobreviver usando esses compostos como fonte de energia. Mas, muitas vezes, ocorre a troca de genes que conferem resistência a antibióticos – e isso é de muita importância para a saúde pública. Esses genes existem na natureza naturalmente, porque existem muitos organismos que produzem antibióticos para se defender contra outros microrganismos.
"Quando as pessoas falam de vírus, normalmente acham que são agentes do mal. No entanto, talvez os seres replicativos mais abundantes na face da Terra sejam exatamente os vírus que infectam bactérias – chamados bacteriófagos"
Então esses microrganismos estão presentes na natureza? Exatamente! Aliás, antibióticos são produtos naturais que extraímos de fungos, bactérias, plantas e outras fontes naturais. Esses genes que codificam essas proteínas e dão resistência também estão sendo trocados entre as bactérias. Quando utilizamos antibióticos com muita frequência, estamos essencialmente selecionando na natureza e dando vantagem para bactérias resistentes contra esses antibióticos. E essa resistência é quase inevitável. Qualquer antibiótico vai conseguir matar 1 bilhão de bactérias, mas, pelo menos uma vai sobreviver porque vai ter uma mutação. Às vezes, em uma enzima que já existe dentro da bactéria fazendo outra função e que não tem nada a ver com resistência contra antibióticos, uma pequena mutação permite que degrade ou quebre aquele antibiótico. Ou, às vezes, ocorre uma mutação no próprio alvo do antibiótico. O antibiótico desempenha sua função ligando em alguma enzima ou em alguma estrutura dentro da célula, que é importante para a sobrevivência dessa célula. Mas, às vezes, ocorre uma mutação que simplesmente acaba como aquele sítio de ligação.
A troca de genes entre as bactérias também ocorre no corpo humano?
Sim, acontece dentro do corpo humano. Temos uma flora bacteriana natural que nos protege dentro dos nossos intestinos, da nossa pele, da nossa boca. E estamos vivendo com essa flora de maneira simbiótica. Mas, às vezes, algumas bactérias conseguem se estabelecer em alguns ambientes onde nosso sistema imune não consegue combatê-las, por exemplo, no pulmão, no sangue, nos ossos, dentro da bexiga... E isso causa uma desregulação. E, às vezes, essas bactérias secretam toxinas que geram sintomas muito graves como diarreia, febre e outros. Ao usar antibiótico mata-se, nos primeiros dias, a grande maioria das bactérias. Mas, se os antibióticos não são utilizados da maneira correta, podem surgir indivíduos bacterianos resistentes que vão começar a se multiplicar. E depois, continuando a usar os antibióticos, aquele medicamento não vai ter mais efeito. Por isso, às vezes, para superar esse efeito, é preciso dar um coquetel de antibióticos – dois, três, quatro e até cinco antibióticos para infecções bem per-

sistentes. Porque a chance de uma bactéria adquirir resistência contra múltiplos antibióticos simultaneamente é muito menor. Essa é a mesma lógica do tratamento de AIDS com um coquetel de antivirais, para citar um exemplo bem conhecido.
Pessoas que tomam antibiótico com muita frequência ou muito precocemente, por exemplo, desde a infância, podem ser candidatas a criar resistência bacteriana?
O tratamento com antibióticos deve ser prescrito realmente somente em casos de infecção bacteriana, e não se deve dar antibióticos para infecções virais, por exemplo. Mas os médicos estão bem atentos a esse fato. O maior problema é o que esse consumo exagerado de antibióticos provoca na população geral, não apenas em um indivíduo. Porque se a população geral está consumindo antibióticos demais, existe maior chance de surgimento de cepas resistentes. E essas cepas vão circular dentro do ambiente e vão causar infecções mais difíceis de tratar no futuro. Esse uso exagerado não é somente na população, mas também na agricultura, em animais e em todo o ambiente. Assim, o uso exagerado está criando maiores chances de surgirem cepas com resistência contra esses antibióticos.
Qual é o papel dos vírus para esse controle microbiológico?
Quando as pessoas falam de vírus, normalmente acham que são agentes do mal, por causa de Covid, HIV e outros. No entanto, tal-
vez os seres replicativos mais abundantes na face da Terra sejam exatamente os vírus que infectam bactérias – chamados de bacteriófagos. E podemos encontrar esses bacteriófagos em todos os lugares onde se encontram bactérias, ou seja, no solo, na água de rios, lagos e oceanos, e associados com material vegetal. E dentro de nós também. Esses bacteriófagos que, às vezes, são chamados simplesmente de fagos, são vírus que infectam bactérias e são muito específicos para certas espécies bacterianas. Quer dizer, para cada espécie de uma bactéria, provavelmente existem pelo menos alguns bacteriófagos que conseguem infectá-las.
E como isso ocorre?
Essencialmente, o vírus tem alguma estrutura feita de proteína que forma um capsídeo, um envelope, dentro do qual tem o material genético desse vírus. Esse material genético pode ser DNA ou RNA. O bacteriófago também tem proteínas associadas com esse capsídeo em uma cauda, que pode ser curta ou comprida, e reconhece algo na superfície da bactéria que evoluiu para infectar. Uma vez que reconheceu a superfície bacteriana, o vírus injeta seu DNA ou RNA dentro da célula bacteriana. E quando o DNA entra na célula pode simplesmente ser replicado em várias cópias e ser transcrito e traduzido para produzir partículas virais. Então, a célula bacteriana fica cheia de centenas de partículas de fago, até eventualmente a célula se romper e os vírus serem liberados para o ambiente onde vão infectar bactérias vizinhas. Outra possibilidade é quando o DNA entra na bactéria e, em vez de ser replicado, simplesmente se insere dentro do genoma dessa bactéria e fica lá replicando com o DNA dela. Cada vez que a bactéria replica seu DNA, o DNA do vírus, que está inserido dentro do cromossomo bacteriano, se replica também. E todos os descendentes daquela bactéria originalmente infectada agora têm o genoma do vírus.
E o que acontece a partir disso?
Normalmente, esse vírus fica dormindo lá por um tempo até algum sinal ambiental induzir a sair, replicar e lisar a bactéria. Normalmente, esse sinal ambiental é al-
gum tipo indicando que a bactéria na qual o vírus está ‘pegando carona’ está estressada e talvez vá morrer. Então, talvez seja o momento de ele sair. Ou, às vezes, a saída é induzida quando o vírus percebe que a população bacteriana é grande, porque bactérias têm maneiras de se comunicar entre si e de saber quantas outras da mesma espécie estão por perto. Em inglês, esse fenômeno é chamado quorum sensing, ou seja, é uma percepção de que tem outras bactérias por perto. Às vezes, um bacteriófago vai usar isso como sinal de que deve sair agora porque tem outras bactérias que pode infectar. E essa entrada e saída dos bacteriófagos e do DNA misturando com o DNA das bactérias é outro mecanismo pelo qual bactérias podem adquirir novos genes, porque o DNA do bacteriófago pode entrar no genoma do cromossomo bacteriano e, às vezes, sofre alguma mutação e não consegue sair mais. Então, fica o resquício do DNA do fago que passa a fazer parte do DNA da bactéria e vai ficar lá para sempre. Se o fago tem genes de resistência contra antibióticos, pode carregar genes de resistência contra antibióticos também.
Vírus que atacam bactérias podem evitar o descontrole bacteriano? Importante lembrar que esses vírus também podem ser benéficos para as bactérias, e existem alguns bacteriófagos que, quando se replicam, conseguem sair da bactéria sem matá-la. No entanto, o nosso interesse é utilizar bacteriófagos para matar bactérias – os chamados bacteriófagos líticos, que causam lise bacteriana. Esses bacteriófagos líticos foram descobertos no fim do século XIX, e o potencial de uso para matar bactérias foi quase imediatamente reconhecido. Nas décadas de 1920 e 1930, na Europa Oriental, especialmente na ex-União Soviética, foram utilizados bacteriófagos para tratar infecções bacterianas em larga escala. Mas, quando os antibióticos foram descobertos, o ocidente os adotou como maneira principal para tratar infecções bacterianas. Além disso, ainda havia um desconhecimento sobre o que é um bacteriófago de verdade e como funciona. Com isso, no ocidente o uso deles como maneira de tratar infecções bacterianas não foi muito explorado até
recentemente. Nas últimas décadas, e está sendo mais e mais hoje em dia, vários países começaram a explorar bacteriófagos para tratamento compassivo de infecções bacterianas que são resistentes aos tratamentos de antibióticos. Por exemplo, seria indicado para pacientes com infecção recorrente que já usaram vários tratamentos ou várias combinações de antibióticos e não conseguiram controlar a infecção, ou, às vezes, quando a infecção é controlada, mas volta. Para esses casos compassivos, o uso de bacteriófagos está sendo explorado para tratar essas infecções em alguns centros médicos no mundo, muitas vezes, em combinação com os antibióticos. Deve-se pensar em estratégias e não usar só uma arma, mas sim uma combinação de armas simultaneamente para que a bactéria não consiga desenvolver resistência contra múltiplos antibióticos e também contra múltiplos bacteriófagos – porque as bactérias podem desenvolver resistência contra bacteriófagos também. E essa resistência acontece naturalmente. Portanto, a melhor estratégia é utilizar um coquetel de vários bacteriófagos que infectam aquela espécie bacteriana específica.
Como esses bacteriófagos estão sendo utilizados atualmente?
Esse é o grande desafio, mas há duas maneiras. Primeiro, em certas regiões, o acompanhamento das infecções bacterianas pelos profissionais da saúde já pode identificar certas linhagens bacterianas que estão aparecendo com frequência na população, causando infecções resistentes a múltiplas drogas. Neste caso, a comunidade pode se prevenir tentando pegar essas cepas mais prevalentes para identificar bacteriófagos que conseguem matar essas bactérias. Assim, podemos criar um banco de bacteriófagos para que, quando surgir uma infecção resistente, tenhamos uma coleção que possa matar aquela espécie bacteriana. O médico que tenha um paciente com infecção persistente, por exemplo, pode passar uma amostra dessa bactéria para os pesquisadores que gerenciam esse banco e eles podem, essencialmente, testar as dezenas ou centenas de bacteriófagos contra aquela cepa particular do paciente. Nesse banco podemos
ter cinco, seis ou 10 bacteriófagos que, pelo menos no laboratório, estão matando a bactéria que está infectando aquele paciente. E, assim, podemos gerar uma mistura e purificar os bacteriófagos para testar se essa formulação está segura, sem toxinas e se os bacteriófagos que estão dentro dela não têm genes que dão resistência contra outros antibióticos. Após todo o controle de qualidade, e seguindo protocolos bem avaliados e aprovados, a ideia é que essa mistura de bacteriófagos possa ser dada para os médicos tratarem infecções resistentes. E realmente, em muitos casos, já foi mostrado que isso é eficaz.
Na Medicina, ainda há resistência para o uso desse tipo de estratégia?
Existem resistências e acho que a estratégia na primeira recorrência é o uso de antibióticos. Se não funcionarem, o médico vai partir para o uso de bacteriófagos. A grande maioria dos bacteriófagos é altamente específica para certa linhagem bacteriana. Então, essencialmente, para cada caso é preciso identificar um conjunto de bacteriófagos que mate aquela linhagem bacteriana que está se reproduzindo naquele paciente. Pelo menos até agora, não temos bancos ou coleções de bacteriófagos tão amplas já prontas para matar qualquer bactéria. Mas a ideia é que possamos aumentar a abrangência dessas coleções para que, no futuro, sejam sempre atualizadas frente ao surgimento de novas cepas bacterianas resistentes, para que a velocidade para montar uma coleção de bacteriófagos que mata uma bactéria seja mais rápida. Por enquanto, cada país está tentando montar um sistema para tratar esses casos. Mas um sistema bem amplo e que pode ser aplicado de um modo geral, por enquanto, não existe.
Bactérias, em geral, são muito resilientes às tentativas de combatê-las? As bactérias estão se protegendo contra bacteriófagos por bilhões de anos. Aliás, a técnica CRISPR de aplicações de biotecnologia para modificação do DNA de uma célula, que ficou famosa nos últimos anos, é um tipo de imunidade das bactérias contra bacteriófagos. A bactéria consegue ter a ‘memória’ de que seus ancestrais já foram infectados por aquele bacteriófago.
Pelo menos até agora, não temos bancos ou coleções de bacteriófagos tão amplas já prontas para matar qualquer bactéria. Mas a ideia é que possamos aumentar a abrangência dessas coleções...
Às vezes, quando o bacteriófago entra na bactéria, ela consegue se proteger e colocar um pedacinho de DNA desse bacteriófago, de mais ou menos 20 ou 30 nucleotídeos, dentro do seu cromossomo. E utiliza essa sequência como uma memória. Assim, se perceber essa sequência de novo, montará uma defesa para quebrar aquele DNA. E o CRISPR é baseado nesse sistema de proteção contra infecções de bacteriófagos. Nos anos 1970, na grande revolução de DNA recombinante, foram desenvolvidas várias enzimas que permitem que o pesquisador corte um pedaço de DNA específico. Essas enzimas que reconhecem sequências de DNA específicas são chamadas de enzimas de restrição e, essencialmente, estão se protegendo contra pedaços de DNA exógenos. Esses pedaços de DNA podem ser plasmídeos ou bacteriófagos. E as bactérias carregam enzimas que reconhecem sequências de DNA exógena, e as matam. Porque, como estão sempre sendo invadidas, querem se proteger contra essas invasões.
Como o ser humano pode se proteger de tanta esperteza das bactérias? É uma guerra constante, como uma guerra fria. Durante a nossa vida, temos de tentar deixar as bactérias sob controle. E, eventualmente, vamos perder a guerra. Aliás, no final de nossas vidas, as bactérias vão ganhar realmente. Mas vamos
tentar aproveitar a vida antes que esse dia chegue. Assim, manter a limpeza e a higiene pessoal, assim como ter uma dieta balanceada para deixar o organismo saudável, são atitudes que ajudam muito. Quando o organismo é saudável, as chances de que uma infecção bacteriana se instale é bem reduzida.
Quais são os principais objetivos dos estudos do CEPID B3?
Esse é um centro de pesquisa com 22 pesquisadores do Estado de São Paulo, cujo recurso financeiro vem principalmente da Fundação de Amparo à Pesquisa do Estado de São Paulo (Fapesp). Além do IQ-USP, temos pesquisadores na Faculdade de Ciências Farmacêuticas e Faculdade de Medicina da USP Ribeirão Preto, Universidade Estadual de Campinas (Unicamp), Universidade Estadual Paulista (UNESP) e no Instituto Agrônomo de Campinas. Esses pesquisadores estão interessados em bactérias em termos gerais e em vários aspectos dos seus comportamentos, desde questões bem básicas sobre como se replicam, se comunicam e competem entre si. E também estudamos bactérias que infectam plantas. Por exemplo, meu laboratório estuda há muito tempo uma bactéria que infecta laranja, chamada Zantomonocytre. E também temos um grande grupo que estuda bacteriófagos que infectam bactérias que atacam plantas, animais e seres humanos. Um dos projetos foi iniciado pela professora Aline Maria da Silva, que era a vice-diretora do nosso instituto e, infelizmente, faleceu em 2024. Ela instalou uma linha de fagoterapia em colaboração com médicos do Hospital das Clínicas da Faculdade de Medicina da USP. Queremos dar continuidade a essa linha de pesquisa e tentar instalar um protocolo inicial de fagoterapia. Já há uma grande coleção de bactérias isoladas clinicamente e muitas são resistentes a múltiplas drogas. A ideia é que, em colaboração com essa equipe médica, possamos gerar ou isolar bacteriófagos que matem as bactérias mais frequentemente encontradas em infecções no Estado de São Paulo atualmente. Assim, as equipes médicas terão essa outra opção para usar em conjunto com tratamentos tradicionais usando antibióticos. •
DOENÇA SE CARACTERIZA
PELA SUBSTITUIÇÃO PROGRESSIVA DO TECIDO HEPÁTICO SAUDÁVEL POR TECIDO CICATRICIAL
Fernanda Ortiz
Especial para Super Saudável
Silenciosa, a cirrose é uma doença crônica e progressiva que acomete o fígado, órgão vital para o funcionamento do corpo humano. A enfermidade é um grave problema de saúde pública global e a causa de milhares de mortes anuais, gerando grandes custos para o sistema de saúde em todo o mundo. No Brasil, de 2019 a 2022 foram registrados 47.444 óbitos por cirrose hepática, segundo o Sistema de Informações sobre Mortalidade (SIM), disponível no DATASUS. A maior prevalência de mortes ocorreu entre homens (71,01%) e em indivíduos com idades entre 55 e 74 anos. Caracterizada pela substituição progressiva do tecido hepático saudável por tecido cicatricial (fibrose) não funcional decorren-

te de um processo inflamatório ou dano persistente, a condição impede o fígado de funcionar adequadamente levando a uma série de complicações graves. Entre os exemplos estão acúmulo de líquido na cavidade abdominal (ascite), hemorragia no trato digestivo, hipertensão portal e câncer, que podem evoluir para a falência total do órgão.
Considerado o laboratório central do corpo humano, o fígado é um órgão vital e responsável por uma série de funções.
Ao atuar em conjunto com outros órgãos para a manutenção de funções fisiológicas, auxilia na digestão das gorduras pela produção de bile, armazena vitaminas e minerais essenciais, extrai e armazena
O diagnóstico da cirrose é realizado através da história clínica do paciente e exames laboratoriais, a exemplo das sorologias e anticorpos de hepatites, para identificar qual doença subjacente atua como causa. Além disso, análises de sangue são utilizadas para avaliar a função do fígado dosando, por exemplo, os produtos de metabolismo da bile (bilirrubina), fatores de coagulação, plaquetas e enzimas específicas. O médico Hugo Cheinquer afirma que exames de imagem como a ecografia, tomografia computadorizada
abdominal e elastografia hepática permitem avaliar o grau de fibrose. Já a biópsia possibilita identificar a extensão dos danos no órgão. Nos últimos anos, foram desenvolvidos métodos não invasivos para a avaliação da fibrose hepática, a exemplo dos biomarcadores séricos. Dentre eles estão o índice FIB-4 (Fibrosis-4), um escore feito a partir de um cálculo simples que contempla idade do paciente, valores TGO/TGP (transaminases) e plaquetas. “Realizados na rotina laboratorial, esses exames facilitam a avaliação frequente

glicose gerando energia. Além disso, o fígado realiza o metabolismo de toxinas, medicamentos e substâncias absorvidas pelo intestino; regula a coagulação sanguínea e participa dos mecanismos de defesa do organismo. A gastroenterologista e hepatologista Geisa Perez Medina Gomide, coordenadora do Departamento de Clínica Médica da Universidade Federal do Triângulo Mineiro (UFTM), explica que todas as funções do fígado são realizadas por hepatócitos, que são células organizadas em lóbulos hexagonais. “Quando o órgão é danificado por qualquer motivo, alguns hepatócitos morrem. Mas, devido à sua capacidade de regeneração, aqueles que restam se

do paciente e, por isso, são recomendados como avaliação de primeira linha”, informa. Devido ao diagnóstico tardio, a grande maioria dos casos de cirrose é irreversível. Dessa forma, o tratamento consiste em evitar a progressão da doença. Entretanto, as causas iniciais que levaram à cirrose devem receber tratamento de acordo com suas especificidades, o que inclui medicamentos para hepatites virais crônicas ou doenças crônicas metabólicas, por exemplo. “No entanto, as complicações mais urgentes como a ence-
multiplicam e restauram a arquitetura dos lóbulos”, detalha. Entretanto, quando o fígado é afetado continuamente por um fator agressivo que o leva ao limite, seu poder de regeneração pode ser comprometido. Neste caso, a área danificada passa a ser preenchida por tecido cicatricial (fibroso) e pela formação de nódulos, o que desorganiza a arquitetura original do órgão. Assim, a proliferação do tecido fibroso leva à perda do tecido funcional do fígado, que não pode ser recuperada. Além de interferir na função hepática, essa fibrose pode bloquear o fluxo sanguíneo da veia porta – que transporta sangue do intestino para o fígado –, resultando em hipertensão portal nas veias do estômago, esôfago, baço ou reto. “À medida que a fibrose progride e os nódulos aumentam, o órgão se retrai e fica mais rígido, o que se traduz pelo quadro de cirrose”, descreve a médica. Portanto, por ser o estágio final de muitas condições crônicas do fígado, a cirrose é um processo lento e silencioso resultante de uma doença que se desenvolve ao longo de muitos anos.
Apesar de ser popularmente associada ao alto consumo de álcool, a doença atualmente tem como principais causas as hepatites virais e a esteatose hepática (gordura no fígado) em decorrên-
cia do crescente aumento do sobrepeso e da obesidade. O médico gastroenterologista e hepatologista Alberto Farias, professor titular do Departamento de Gastroenterologia e Hepatologia da Faculdade de Medicina da Universidade de São Paulo (FMUSP) acrescenta que, nos últimos anos, tem crescido o número de pessoas acometidas por cirrose secundária à esteatose hepática, que está relacionada principalmente à obesidade. “Esses quadros são impulsionados pelo estilo de vida sedentário e por padrões de alimentação inadequados constituídos pelo alto consumo de alimentos ultraprocessados, ricos em gordura, açúcar e aditivos químicos”, acentua. Além disso, doenças da tireoide e síndrome metabólica podem contribuir para a esteatose hepática e, consequentemente, para o desenvolvimento da cirrose.
Os sintomas da cirrose dependem, em grande parte, da fase em que a doença se encontra. “Os estágios iniciais – fase compensada – geralmente são assintomáticos. Mas, conforme a doença progride, surgem sinais como perda de peso, fraqueza ou anorexia. “Na maio-
ria dos casos, os sintomas se manifestam tardiamente, quando a fase já está descompensada e a cirrose já está em estágio muito avançado e com quadro irreversível”, observa o médico gastroenterologista Hugo Cheinquer, do Serviço de Gastroenterologia do Hospital das Clínicas de Porto Alegre (HCPA) e professor titular da Faculdade de Medicina da Universidade Federal do Rio Grande do Sul (UFRGS). Na fase descompensada, o paciente pode apresentar icterícia na esclera, na pele e nas mucosas; inchaço abdominal provocado pela retenção de líquidos (ascite); edemas em pernas, tornozelos e pés; prurido e eritema palmar. Também ocorrem perda de função cerebral (encefalopatia hepática), que surge quando o fígado perde a capacidade de remover as toxinas do sangue; insuficiência renal (síndrome hepatorrenal); hemorragia digestiva alta varicosa e carcinoma hepatocelular em estágios mais avançados, entre outros.

falopatia hepática ou a hemorragia digestiva devem ser tratadas de forma prioritária”, orienta a médica Geisa Perez Medina Gomide. Pacientes com cirrose avançada geralmente são candidatos a transplante de fígado, com critérios de elegibilidade que incluem estágio da doença e causa da falência hepática. Quando não rastreada, acompanhada e tratada adequadamente, outra complicação severa da cirrose é o desenvolvimento de tumores no fígado que favorecem a manifestação do câncer hepático.
A prevenção se baseia na eliminação dos fatores causadores e um deles é a redução (ou suspensão) do consumo de bebidas alcoólicas, especialmente para quem já apresenta predisposição a doenças hepáticas. Além disso, manter o controle do peso, do diabetes e do colesterol, e adotar um estilo de vida mais saudável que inclua alimentação equilibrada e atividades físicas regulares, é fundamental. Em relação às hepatites virais, deve ser feita a testagem através de exames laboratoriais específicos
– realizados nas consultas de rotina – e a imunização contra a hepatite B, disponível no Sistema Único de Saúde (SUS). Além disso, a adoção de medidas preventivas como uso de preservativo nas relações sexuais e o não compartilhamento de seringas e objetos de uso pessoal, como alicates e lâminas de barbear, são importantes. “A proteção contra as hepatites e o controle do peso são as melhores maneiras de evitar que o fígado sofra danos progressivos”, sinaliza o gastroenterologista Hugo Cheinquer.
jul/set 2025 • Super Saudável


Recentemente, uma pesquisa coordenada pela FMUSP constatou que a carga genética de ancestralidade indígena está associada ao maior risco de desenvolver cirrose grave e insuficiência hepática. O estudo ‘Prevalência, Epidemiologia, Caracterização e Mecanismos da Síndrome de Falência Aguda sobre Crônica do Fígado (ACLARA)’ – promovido e patrocinado pela Fundação Europeia para Estudo do Fígado (EF-CLIF) –, reuniu pesquisadores de 44 hospitais em sete países latino-americanos. O levantamento sugere que a ancestralidade genética pode estar relacionada a uma resposta inflamatória mais intensa no fígado. Entretanto, investigações futuras são necessárias para identificar os genes envolvidos neste processo.
Ao comparar informações genéticas de pessoas com ascendência nativo-americana (DNA de origem indígena) com grupos de ascendência europeia e africana, o estudo de coorte prospectivo analisou um conjunto abrangente de dados de 1.274 pacientes com cirrose agudamente descompensada, internados de forma não eletiva. “Investigamos o peso da ancestralidade e da raça nos pacientes com diagnóstico de cirrose grave, condição caracterizada por inflamação, falência de órgãos e alto risco de mortalidade em curto prazo”, descreve o professor Alberto Farias, que é coautor do estudo e coordenador da Rede Internacional de Pesquisa em Cirrose ACLARA. De acordo com os resultados, a cada 10% de ancestralidade nativo-americana aumenta em 8% o risco de forma grave de cirrose. Dessa forma, mesmo sem desconfiar, qualquer pessoa que tenha ancestralidade genética indígena se enquadraria neste perfil.
O professor comenta, ainda, que a pesquisa não se limitou a analisar as características raciais, pois um indivíduo pode ter traços físicos de uma raça e parte da carga genética de outra. “Essa condição é muito comum em países com processos de formação, a exemplo dos latino-americanos, onde ocorreu a miscigenação dos povos”, relata. Além dos achados neste estudo, a possibilidade de identificar pessoas com maior risco de desenvolver formas graves de cirrose poderá ser levada em consideração para futuros programas de Medicina de Precisão, preconizando a singularidade de cada paciente. Isso possibilitará um planejamento individualizado, diagnósticos precoces, tratamentos mais eficazes e, consequentemente, desfechos mais positivos. O artigo ‘Genetic ancestry, race, and severity of acutely decompensated cirrhosis in Latin America’ foi publicado na revista científica Gastroenterology em 2022. •

Nativa da Mata Atlântica e uma das joias da flora brasileira, a jabuticaba é conhecida pelo seu sabor inconfundível e também pelos inúmeros benefícios oferecidos à saúde. Pertencente à família Myrtaceae e utilizada tradicionalmente na alimentação, a fruta é rica em compostos bioativos, antocianinas, fibras e micronutrientes – propriedades responsáveis por conferir os efeitos antioxidantes e anti-inflamatórios. Versátil e com polpa suculenta, a jabuticaba tem sido objeto de diversas pesquisas que apontam para seu potencial terapêutico. Achados na literatura comprovam que especialmente as substâncias presentes na casca atuam no controle da hiperglicemia, da síndrome metabólica e do bom funcionamento intestinal. Além disso, ajudam na prevenção do aumento do acúmulo de gordura no fígado e na modulação do declínio cognitivo.
Considerada uma ‘berry brasileira’, a jabuticaba contém uma variedade de nutrientes essenciais para a saúde humana. De acordo com a professora doutora Mariana Sarto Figueiredo, docente do Departamento de Nutrição Dietética e coordenadora do Grupo de Pesquisa em Nutrição e Programação Metabólica e do Laboratório de Nutrição Experimental da Faculdade de Nutrição da Universidade Federal Fluminense (UFF), a fruta possui elevada quantidade de fibras alimentares, baixo teor de gorduras e alta concentração de carboidratos. “Entre os principais micronutrientes estão as vitaminas C, E, do complexo B (como B1, B2 e B3) e ácido fólico, que desempenham um papel importante na melhora do sistema imunológico e na proteção das células contra danos oxidativos”, descreve. A fruta também é uma excelente fonte de fibras, o que ajuda a melhorar o funcionamento do intestino e o controle de peso. Além disso, é rica em minerais como ferro, potássio, selênio, cálcio, zinco, magnésio

e fósforo que, juntos, contribuem para o fortalecimento dos ossos, melhoram a circulação sanguínea e promovem o equilíbrio eletrolítico.
Por ser extremamente rica em compostos bioativos, especialmente polifenóis, antocianinas (responsáveis pela coloração roxa intensa), flavonoides, ácidos fenólicos e fibras alimentares, a jabuticaba é considerada um alimento funcional. “Essas propriedades conferem à fruta potenciais efeitos antioxidantes, anti-inflamatórios, hipoglicemiantes e moduladores da saúde cardiovascular”, destaca a engenheira agrônoma Elizabeth Aparecida Ferraz da Silva Torres, professora associada do Departamento de Nutrição da Faculdade de Saúde Pública da Universidade de São Paulo (FSP-USP). Especialmente as antocianinas e outros polifenóis bioativos têm uma poderosa ação antioxidante, capaz de neutralizar os radicais livres no organismo e, assim, proteger as células de danos oxidativos. Sendo assim, estão associados à prevenção de diversas enfermidades crônicas não transmissíveis a exemplo de câncer, doenças cardiovasculares e neurodegenerativas e distúrbios metabólicos.
Segundo a professora Mariana Sarto Figueiredo, todas as estruturas da fruta possuem compostos bioativos e propriedades promotoras de saúde. A polpa contém ferro, fósforo, vitamina C e niacina, uma vitamina do complexo B. No entanto, a casca da jabuticaba – geralmente descartada por causa do sabor adstringente – é particularmente mais rica em fibras e em compostos fenólicos. “Estes compostos interferem no metabolismo da glicose e estimulam a liberação de insulina na célula pancreática”, descreve. As sementes, muitas vezes desprezadas, também

apresentam propriedades interessantes. Alguns achados na literatura relatam que essa estrutura da fruta pode contribuir para o controle da obesidade, além de apresentar potencial anti-inflamatório.
Embora o consumo in natura seja o mais comum, a jabuticaba também pode ser usada na produção de sucos, geleias, licores, vinhos e molhos para pratos doces e salgados. Ademais, pode ser utilizada na forma de farinha para deixar pães, biscoitos e vitaminas muito mais coloridos e saborosos. “Embora

exista uma recomendação oficial padronizada, é possível sugerir o consumo de uma porção de 100g a 150g de jabuticabas frescas por dia, sempre que disponível, como parte de uma alimentação equilibrada e variada”, orienta a professora Elizabeth Aparecida Ferraz da Silva Torres. Entretanto, no caso de suplementos e produtos processados (como farinha ou extrato da casca), as dosagens precisam seguir recomendações específicas baseadas nos estudos científicos e nas orientações de um nutricionista ou profissional da saúde.
Pesquisas desenvolvidas no Laboratório de Nutrição e Metabolismo (Lanum) da Faculdade de Engenharia de Alimentos da Universidade Estadual de Campinas (FEA-Unicamp) atestam os benefícios do consumo da casca da jabuticaba no controle e tratamento de determinadas doenças. Substâncias como as antocianinas presentes especificamente nessa parte da fruta atuam, por exemplo, nos níveis de inflamação e de glicose no sangue de indivíduos com síndrome metabólica e obesidade. Além disso, ajudam na prevenção e modulação do declínio cognitivo leve – quadro que antecede o processo de demência – e na modulação da saúde intestinal. Os cientistas consideram sua ação surpreendente até mesmo para monitorar os índices glicêmicos entre indivíduos saudáveis.
Os estudos são liderados pelo professor doutor Mário Roberto Maróstica Junior, docente do Departamento de Ciência dos Alimentos e Nutrição da Unicamp. O experimento revelou que o consumo diário de pelo menos 15 gramas da casca da fruta pela manhã, ao longo de cinco semanas, melhorou os níveis de inflamação e de glicose no sangue de indivíduos com sín-
drome metabólica e obesidade. Dos 49 participantes, uma parte recebeu um suplemento diário de casca de jabuticaba, enquanto os demais ingeriram placebo. Além de exames de sangue para monitorar a glicemia, todos passaram por avaliação das medidas antropométricas, pressão arterial e parâmetros inflamatórios – como a interleucina-6 (IL-6), considerada um marcador de inflamação relacionada à obesidade. O estudo apresentou resultados positivos em relação à diminuição da glicemia pós-prandial (monitorada ao longo de duas horas após a ingestão) e aos níveis de inflamação no grupo que recebeu o suplemento. “Isso ocorre porque os compostos fenólicos e as fibras presentes na casca da jabuticaba têm o poder de modular a atividade antioxidante e anti-inflamatória, e podem estar relacionadas com a ação e liberação de insulina. Portanto, exercendo efeito no perfil glicêmico”, explica o professor. Os achados apontam, ainda, que mesmo em indivíduos saudáveis a glicemia costuma aumentar após as refeições, voltando depois aos níveis normais. Desta forma, ao abaixar a glicemia após uma

refeição o suplemento possibilita que o indivíduo mantenha os níveis controlados ao longo do tempo, contribuindo para uma vida mais saudável. O artigo ‘Jaboticaba peel improves postprandial glucose and inflammation: A randomized controlled trial in adults with metabolic syndrome’ foi publicado no periódico Nutrition Research em 2024.
Em um estudo de 2018, os pesquisadores observaram in vivo que o extrato da
Trabalhos mais recentes têm investigado os efeitos do consumo da casca de jabuticaba com relação à obesidade e ao declínio cognitivo leve, especialmente pela resistência à insulina central, que leva à diminuição da atividade e da modulação de algumas enzimas relacionadas à ação cognitiva. Entre elas, as proteínas Beta amiloide e TAU fosforilada são marcadores relacionados à doença de Alzheimer. O professor Mário Roberto Maróstica Junior explica que o objetivo do experimento foi avaliar a memória e os marcadores centrais relacionados à memória. Para isso, foram realizados testes in vivo com animais com obesidade induzida divididos em quatro grupos: magro, grupo com jabuticaba, grupo obeso e obeso com jabuticaba. Todos os marcadores relacionados à glicose, insulina e inflamação se repetiram, como em estudos anteriores. “Observamos que os animais obesos tinham uma clara melhora nos marcadores bioquímicos relacionados à memória, quando comparados aos magros. Entretanto, os animais obesos que receberam o extrato da jabuticaba apresentaram uma reversão da perda de memória e dos marcadores relacionados à cognição. Com isso, passaram a experienciar o comportamento observado no padrão saudável (no caso, mais magro), evidenciando o
potencial terapêutico da fruta para a modulação do declínio cognitivo”, detalha. Atualmente, o grupo tem estudado tais efeitos em humanos com grandes possibilidades de sucesso.
Além disso, evidências apontam que o efeito das substâncias da casca da jabuticaba também ajuda na modulação da microbiota intestinal. “Em um primeiro momento, realizamos um estudo in vivo com animais obesos e verificamos a modulação positiva principalmente da Akkermansia muciniphila, uma bactéria benéfica relacionada ao metabolismo da glicose”, comenta o professor. A partir desses resultados, o próximo passo foi testar a relação do extrato com a modulação da doença inflamatória intestinal. Por meio de estudo in vivo com indução de colite, os achados evidenciaram uma melhora nos marcadores inflamatórios relacionados à doença. Na sequência, um novo estudo in vivo com indução química de câncer colorretal registrou uma diminuição do número de tumores e modulação de biomarcadores associados. De acordo com o professor, todos os achados evidenciam que o uso do extrato da casca da jabuticaba, independentemente do mecanismo, é um aliado importante para a melhora da saúde intestinal. •

casca da jabuticaba foi capaz de prevenir o pré-diabetes e a esteatose hepática. “A ingestão do extrato por camundongos envelhecidos submetidos à dieta com alto teor de gordura (cinco vezes mais lipídios do que a dieta normal) levou à diminuição no ganho de peso, na dislipidemia e hiperglicemia”, descreve o professor. Além disso, aumentaram os níveis de HDL-colesterol e a atividade de receptores relacionados à insulina, promovendo melhora na morfologia do fígado. O estudo foi realizado com amostras em processo de envelhecimento (associado diretamente à redução da capacidade metabólica e alterações do metabolismo hepático, glicídico e lipídico) para avaliar o limite da dose do extrato que pode ser consumida para promover efeitos benéficos. O artigo ‘Jaboticaba extract prevents prediabetes and liver steatosis in high-fatfed aging mice’ foi publicado no Journal of Functional Foods.

Elessandra Asevedo Especial para Super Saudável
Adoença de Parkinson dobrou em prevalência nos últimos 25 anos e as estimativas globais mostram que mais de 8,5 milhões de indivíduos estão vivendo com a enfermidade. A incapacidade e a morte devido à doença também estão aumentando mais rápido em relação a qualquer outro distúrbio neurológico. Os últimos dados, publicados em 2019, mostram 5,8 milhões de vidas marcadas pela incapacidade e 329 mil mortes – com aumento de 81% e 100%, respectivamente, desde 2000. Esse cenário epidemiológico preocupa a saúde pública e é agravado pela falta de cura para esta doença multifatorial, crônica e progressivamente incapacitante.
A origem da enfermidade está relacionada a uma combinação de fatores ambientais, como a exposição a infecções, poluição do ar, detergentes e pesticidas, assim como câncer, lesão cerebral traumática, dieta e a própria composição da microbiota intestinal. Vários estudos préclínicos têm se dedicado a explorar novos tratamentos para a doença de Parkinson, e o eixo intestino-cérebro vem emergindo como um caminho de intervenção promissor. Publicações científicas mostram que diferentes espécies bacterianas pertencentes aos gêneros Lactobacillus, Streptococcus e Bifidobacterium podem proteger modelos animais de neurodegeneração e deficiên-
cias motoras, bem como inflamação intestinal e neural, quebra da barreira epitelial intestinal e constipação. Além disso, a influência da disbiose intestinal em outras enfermidades neurodegenerativas já está bem evidenciada, a exemplo de doença de Alzheimer, esclerose lateral amiotrófica e esclerose múltipla.
No entanto, os estudos sobre o eixo intestino-cérebro na doença de Parkinson são quase exclusivamente sobre a ecologia bacteriana intestinal e ignoram o papel potencial dos vírus e fungos. Este ponto chamou a atenção de pesquisadores brasileiros, que realizaram uma revisão da literatura com o objetivo de abordar os principais aspectos hipotéticos do papel da microbiota e de uma comunidade formada por fungos e leveduras na doença de Parkinson. “Analisamos mais de 100 estudos publicados em diferentes bases de dados científicos do mundo para descobrir o que já se sabia sobre as bactérias. Depois, realizamos pesquisas com as palavras-chave fungos e/ou leveduras”, explica o biólogo Dionísio Pedro Amorim Neto, doutorando da Faculdade de Engenharia de Alimentos da Universidade Estadual de Campinas (FEA-Unicamp).

Inicialmente, o trabalho de doutorado investigava a ação de bactérias e leveduras que participam da fermentação do café, porque algumas publicações apontam que o consumo regular da bebida reduz a propensão de desenvolver Parkinson. Como o trabalho de revisão reforçou que não havia publicações relacionadas a leveduras e outros fungos – apenas a relação das bactérias intestinais com a doença –, o projeto passou a pesquisar também o papel desses microrganismos na enfermidade. O estudo sugere que fungos e leveduras, ou seus metabólitos secundários, poderiam tanto proteger como induzir os principais sintomas clínicos do Parkinson. Os fungos funcionariam, ainda, como peça-chave nas causas e origens da doença.
Além disso, foram encontradas semelhanças entre a ação de bactérias e fungos no eixo intestino-cérebro na enfermidade. “Pesquisas mostram que as bactérias são capazes de inibir o estresse oxidativo e o processo inflamatório intestinal e neuronal, bem como estudos com fungos probióticos sugerem influência em modelos de síndrome do intestino irritável e depressão”, acentua o pesquisador. Ademais, foram observados que extratos de fungos filamentosos são capazes de induzir o estresse oxidativo e matar linhagens de neurônios em laboratórios, sugerindo que fungos intestinais desempenham um papel relevante na doença de Parkinson.

Para o pesquisador e coordenador do Laboratório de Microbiologia Quantitativa de Alimentos da FEA-Unicamp, Anderson de Souza Sant’Ana, orientador da pesquisa, o estudo do microbioma intestinal e sua relação com a doença de Parkinson representa uma promissora fronteira na busca por novas estratégias terapêuticas e preventivas para essa condição neurodegenerativa. “A crescente evidência da comunicação entre o eixo intestino-cérebro destaca o potencial das bactérias ácido láticas na proteção neuronal, especialmente as associadas ao café. Além disso, reforça a importância do conhecimento da microbiota dos alimentos e de processos fermentativos, que podem contribuir também com esses benefícios”, pontua.
Ao investigar a ação neuroprotetora dessas bactérias em modelos da doença de Parkinson esporádica, os cientistas esperam não apenas ampliar o entendimento sobre os mecanismos envolvidos na condição, mas também abrir caminho para intervenções inovadoras e acessíveis. “No futuro, esse conhecimento pode levar ao desenvolvimento de novas abordagens terapêuticas baseadas em probióticos, contribuindo para melhorar a qualidade de vida dos pacientes e para a redução dos custos associados ao tratamento”, sugere o pesquisador Anderson de Souza Sant’Ana. •


O OLFATO APURADO PODE
SER UTILIZADO
PARA DETECTAR PRECOCEMENTE PROBLEMAS DE SAÚDE COMO DIABETES, CÂNCER DE MAMA, COVID E CONVULSÕES DA EPILEPSIA
Mais do que melhores amigos do homem, os cães são famosos por terem um olfato extraordinário graças à sua genética e fisiologia. A literatura indica que os cachorros possuem uma capacidade olfativa que excede em até 40 vezes a observada nos humanos. Isso porque possuem 300 milhões de receptores olfativos – que se diferem conforme a raça – contra 5 milhões do ser humano, o que os torna capazes de sentir odores imperceptíveis para as pessoas. Devido a essa habilidade, cães treinados podem ser usados para trabalhos de resgate, identificação de drogas e artefatos explosivos ou para localizar pessoas e identificar doenças. Estudos têm mostrado que os cães possuem a capacidade de alertar quando vai ocorrer, por exemplo, uma crise de hipoglicemia ou convulsão, e podem identificar diabetes, vid-19 por meio de substâncias produzidas pelo sistema imunológico. Isso ocorre devido ao recesso olfativo, uma estrutura anatômica localizada atrás dos olhos que ocupa metade da parte interna do focinho. Essa espécie de labirinto de vias aéreas ajuda a transportar rapi-
Fernanda Ortiz Especial para Super Saudável damente as moléculas de odor por uma única via, possibilitando que os cães captem odores específicos.

O Projeto KDog Brasil tem treinado cães para detectar precocemente câncer de mama através desses odores específicos emitidos pelo corpo humano. Fruto da parceria com o Instituto Curie, um Centro de Pesquisa e Tratamento de Câncer localizado na França, a pesquisa é liderada pela Sociedade Franco Brasileira de Oncologia (SFBO) e pelo cinotécnico Leandro Lopes, coordenador técnico do KDog Brasil. Os pesquisadores trabalham no desenvolvimento de um método de triagem simples, confiável, respeitoso com os animais, não invasivo e acessível para as mulheres que se enquadram no rastreamento da neoplasia. Mais do que acelerar o diagnóstico, o objetivo desta plataforma científica é ampliar o alcance ao cuidado, especialmente para comunidades localizadas em regiões afastadas e que não têm acesso a métodos de rastreio diagnóstico. O adestramento dos cães incluiu, no primeiro momento, lições de obediência como aprender a procurar algo e sinalizar ao encontrar. Na fase seguinte, foi realizado o pareamento olfativo para diferenciar o odor produzido pelas células de câncer das amostras controle – através de recompensas positivas. O projeto treinou seis cães cujas raças têm como característica o focinho comprido e o número de receptores

ram para determinar se os cães poderiam ser treinados para identificar pessoas recém-infectadas pelo vírus. Com trabalhos em países como Alemanha, Estados Unidos e Finlândia indicando a vocação dos cães para essa finalidade, pesquisadores da Escola Nacional Veterinária de Alfort, na França, e da Universidade Federal Rural de Pernambuco (UFRPE) comprovaram que os cães são capazes de distinguir o odor de um indivíduo infectado. Esse odor é constituído por compostos voláteis que evaporam com o suor, diferentemente do exalado por uma pessoa saudável. “Os cães foram inicialmente treinados com a utilização de polímeros especiais embebidos por catabólitos de pessoas infectadas, além de amostras com teste negativo para Covid-19. Na prática, os animais foram ensinados a reconhecer, através do cheiro do suor, a presença do vírus”, explica
o professor doutor Anísio Francisco Soares, coordenador do Laboratório de Fisiologia e Cirurgia Experimental e do Biotério de Criação e Experimentação do Departamento de Morfologia e Fisiologia Animal (DMFA) da UFRPE, que liderou os trabalhos no Brasil.
A pesquisa envolveu treinamento dos cães, coleta de materiais e identificação das amostras. Os cães foram adestrados pelo cinotécnico Jorge Pereira, da Unidade K9 Internacional, em Campo Limpo Paulista, São Paulo. Enquanto isso, as amostras foram coletadas com ajuda de agentes de saúde em Paudalho, Pernambuco. Os voluntários com sintomas de síndrome respiratória foram orientados a não estar em tratamento, não tomar banho ou usar perfume 48 horas antes da coleta, a fim de evitar interferências no odor. As amostras – cerca de 100 – foram coletadas por meio de bolinhas de algodão esfregadas nas axilas por cerca de 20 minutos. Com duas amostras por paciente,


olfativos em torno de 250 milhões, que ampliam a capacidade de detecção dos odores próprios da doença, imperceptíveis para o olfato humano. “Destes, um pastor alemão e um braco alemão estão inseridos na plataforma científica”, explica o coordenador da KDog. Para o treinamento de pareamento dos odores foram utilizadas amostras com seleção de materiais com e sem a presença de câncer, preparadas por um patologista. Os cães obtiveram quase 100% de acerto nos resultados preliminares, indicando o potencial da metodologia.
Finalizado esse processo, a próxima etapa é o protocolo efetivo com pacientes atendidas na SFBO e com voluntárias saudáveis. Nesta fase, as participantes receberão um kit com gazes esterilizadas com algodão específico, um saco hermético e

uma folha com as instruções de manejo. “Basicamente, as mulheres serão orientadas a lavar as mãos com sabonete neutro antes de dormir, colocar as compressas sobre as duas mamas e retirar ao acordar.
Pela manhã, as compressas deverão ser inseridas no saco hermético e enviadas para o projeto, onde serão submetidas ao olfato dos animais”, descreve o cinotécnico Leandro Lopes. A expectativa dos pesquisadores é que os resultados obtidos nesta etapa corroborem os dados iniciais do estudo, assim como os achados das pesquisas realizadas pelo Instituto Curie (onde o Projeto KDog começou), que constataram 91% de efetividade na detecção do câncer de mama.
Para a médica oncologista Carla Ismael, presidente da SFBO e responsável pela implantação do projeto no Bra-
uma era conduzida para a UFRPE para o teste RT-PCR (padrão-ouro para detecção do RNA do vírus) e a outra diretamente enviada ao canil. No processo de identificação, os cães passavam na frente de dispositivos compostos de pequenos orifícios com as amostras. Ao detectar o odor característico da doença, se sentavam ou latiam e aguardavam a ‘recompensa’. Os primeiros resultados mostraram acertos entre 95% e 97,5%, e se repetiram na fase seguinte, quando os cães foram levados ao ambiente hospitalar. “Durante o processo, um fato chamou atenção: um paciente estava negativo no RT-PCR, mas o faro habilidoso do cão sentiu que existiam vestígios do vírus. Ou seja, mesmo que o paciente já tivesse desenvolvido anticorpos, ainda assim o cachorro foi capaz de identificar os compostos orgânicos pelo suor”, relata o professor Anísio Francisco Soares. O fato corrobora a capacidade dos cães farejadores neste processo.

sil, a ideia é que o farejamento canino sirva como triagem para a mamografia digital – sem substituir o exame. “Nosso anseio é que as pessoas com indicação para fazer o exame de imagem passem por essa pré-análise feita pelos cães. Caso os animais indiquem a possível presença da neoplasia, essa paciente teria prioridade na fila e, portanto, acesso antecipado aos serviços de saúde específicos”, detalha. Pela efetividade do trabalho com os cães e pelo baixo custo, a médica acredita que o projeto possua um grande potencial para, futuramente, ser implantado no Sistema Único de Saúde (SUS) por ser menos oneroso do que mandar kits de detecção para regiões remotas como, por exemplo, comunidades ribeirinhas ou quilombolas, ou mesmo deslocar um mamógrafo até esses locais.
No estudo ‘Exhaled breath isoprene rises during hypoglycemia in type 1 diabetes’, cientistas do Reino Unido demonstraram que os cães conseguem identificar níveis baixos de glicose em indivíduos diabéticos. Segundo os autores, isso é possível porque farejam isopreno, um subproduto da produção de colesterol que cresce consideravelmente durante a hipoglicemia. Ao sentir o odor, o cão treinado pode avisar o paciente e ajudar na prevenção de tontura, desmaios e até coma. Um trabalho desenvolvido na França investigou se existe ‘odor de convulsão’ na epilepsia e se os cães poderiam identificá-lo. Além de provar que realmente ocorrem odores específicos antes das convulsões, todos os cães usados no experimento discriminaram esse odor. O artigo ‘Dogs demonstrate the existence of an epileptic seizure odour in humans’ foi publicado na revista Scientific Reports em 2019. •
Adenilde Bringel
AYakult do Brasil acaba de renovar o patrocínio com a Confederação Brasileira de Desportos Aquáticos (CBDA) para todas as ações da natação brasileira, pelo quarto ano consecutivo. O novo contrato, válido até maio de 2026, envolve todas as ações da natação, inclusive os campeonatos brasileiros absolutos e de categoria que selecionam os atletas para as principais competições internacionais. Em abril, a empresa também assinou um patrocínio com o Instituto Todos Pelo Esporte para o projeto Todos Pela Natação:
Só Para Elas/SP, que oferecerá aulas gratuitas de natação para 200 meninas na cidade de São Paulo. A iniciativa também tem apoio da CBDA.
A filial brasileira é patrocinadora oficial da CBDA desde 2022. “Temos uma grande responsabilidade como empresa
que se preocupa com a saúde e sabemos que, para ter uma vida mais saudável, a prática de exercícios é fundamental. O esporte competitivo também ensina técnica, disciplina e comprometimento, além de forjar no caráter dos atletas a capacidade de respeito ao próximo”, acentua o presidente da Yakult do Brasil, Atsushi Nemoto. O executivo ressalta que a empresa acredita no esporte para propiciar uma vida mais saudável em todas as idades. E essa premissa faz parte da filosofia da Yakult de ‘contribuir para uma vida saudável e alegre das pessoas ao redor do mundo’.
O patrocínio oficial com a Confederação Brasileira de Desportos Aquáticos para os eventos de natação dá direito de a Yakult estampar a marca nas placas de publicidade, nos pódios e backdrops das competições ao longo de todo o ano. Além disso, a empresa realiza algumas ações de degustação de produtos durante os torneios nacionais. No último Campeonato Brasileiro Interclubes Absoluto de Natação – Troféu Maria Lenk, todos os atletas e membros de Comissão Técnica degustaram os leites fermentados da marca e outros produtos disponibilizados em um refrigerador exclusivo.
Para o presidente da CBDA, Diego



Rocha Dias de Albuquerque, a renovação do patrocínio com a Yakult por mais um ano consolida uma parceria sólida e estratégica para o desenvolvimento da natação brasileira. O dirigente acentua que a presença da Yakult reafirma a confiança no trabalho da CBDA e reforça o compromisso da entidade com a excelência esportiva. “Chegamos ao quarto ano consecutivo dessa importante colaboração, que tem contribuído de forma significativa para a estruturação e valorização das nossas principais competições”, destaca.
A Yakult Honsha, matriz sediada no Japão, também é patrocinadora oficial da World Aquatics em seus principais eventos de natação desde 2005. Além disso, a matriz investe no beisebol desde a década de 1990 no Japão, com o time profissional Yakult Swallows. No Brasil, a Yakult mantém o Centro de Treinamento/Academia de Beisebol, em Ibiúna, desde 1999. O CT também é a sede da Academia MLB Brasil, iniciativa conjunta da Confederação Brasileira de Beisebol e Softbol (CBBS) e da Major League Baseball (MLB), principal liga profissional de beisebol dos Estados Unidos.

A longevidade é uma das marcas dos produtos da multinacional japonesa Yakult. Um exemplo é o leite fermentado, que está completando 90 anos em 2025. Outro produto longevo é o alimento à base de extrato de soja Tonyu, que celebra seus 40 anos. Lançado em 1985, o produto foi inteiramente desenvolvido pela filial brasileira da marca. O Tonyu foi um dos primeiros alimentos da categoria no Brasil e, ao longo dessas quatro décadas, passou por algumas mudanças na formulação. Na última alteração, em 2022, foi enriquecido de vitaminas B1, B3, B5, B6, B9, B12, D e zinco e ganhou a embalagem atual.
A grande preocupação da Yakult ao desenvolver o produto, na década de 1980, foi criar um alimento que atendesse totalmente ao gosto do consumidor brasileiro. Assim, o Tonyu


foi ganhando a confiança do consumidor e, hoje, está consolidado no País. “Desde a fundação, a Yakult sempre teve como foco desenvolver alimentos que possibilitem a manutenção da saúde. Por isso, ao longo desses 40 anos fizemos algumas alterações para deixar o Tonyu ainda melhor do ponto de vista nutricional”, ressalta o presidente da filial brasileira, Atsushi Nemoto. Alguns micronutrientes presentes na formulação do Tonyu auxiliam no bom funcionamento do sistema imunológico. Além disso, as vitaminas B6 e B12 ajudam a regular os níveis de homocisteína. Este aminoácido localizado no plasma do sangue está relacionado a doenças cardiovasculares, como infarto e acidente vascular cerebral (AVC). Já a vitamina D exerce um papel fundamental auxiliando na manutenção da massa óssea, enquanto o zinco é um antioxidante que ajuda na proteção dos danos causados pelos radicais livres.
O projeto Todos Pela Natação: Só Para Elas/SP tem como objetivo incentivar a prática esportiva e promover o desenvolvimento físico e social de crianças e adolescentes de 6 a 17 anos. O projeto também contemplará crianças com deficiência motora, reforçando o compromisso do Instituto com a inclusão e a equidade no esporte. O presidente da Yakult do Brasil afirma que o apoio institucional para mais uma atividade ligada à natação reforça o compromisso da empresa com a modalidade e com o esporte de forma ampla. “Acreditamos que o esporte é uma maneira saudável e eficaz de transformar pessoas, e é fundamental quando oferecido para a formação de crianças e jovens”, ressalta.
O superintendente executivo do Instituto Todos Pelo Esporte, Alessandro Ser rato, acrescenta que o foco do ‘Só Para Elas’ é oferecer oportunidades e construir um espaço seguro, acolhedor e inspirador para que as meninas possam aprender e se desenvolver. Este será o segundo maior núcleo do Instituto, que já atende 500 crianças em Vitória, no Espírito Santo, com um projeto semelhante. “Com a expansão do Só para Elas para São Paulo, o Instituto amplia o alcance de suas ações e fortalece sua missão de transformar vidas por meio do esporte”, acentua. •
A intolerância à lactose é uma das desordens genéticas mais comuns no mundo, atingindo mais de 46% da população global. Esse problema ocorre devido à diminuição da atividade da enzima lactase para hidrolisar o principal carboidrato do leite (lactose) na mucosa do intestino delgado. Como o Tonyu tem como base uma proteína vegetal, também é indicado para pessoas com esse problema ou, ainda, que têm alergia à proteína do leite de vaca (APLV). A soja contém uma grande quantidade de isoflavonas, que são substâncias com importantes atividades antioxidante e anticancerígena. Nos últimos anos, estudos têm comprovado que o consumo do grão contribui para a diminuição das incidências de câncer de mama, útero e próstata. Além disso, a soja pode auxiliar no controle dos sintomas da menopausa e na melhora dos níveis de colesterol. •
O Caminho da Fé foi inspirado no Caminho de Santiago de Compostela, que passa por França e Portugal e termina na Espanha. O circuito nacional foi idealizado e desenvolvido para dar estrutura aos peregrinos que seguem até o Santuário Nacional de Aparecida, no interior de São Paulo. O caminho inteiro tem mais de 2000km e é composto por 71 cidades localizadas nos Estados de São Paulo e Minas Gerais. Desses, aproximadamente 400km atravessam montanhas da Mantiqueira com trilhas, bosques e trechos de asfalto. Além de belas paisagens, comunidades acolhedoras atendem os peregrinos ao longo do caminho. Setas amarelas e sinalização específica da trilha auxiliam os peregrinos que seguem a pé, de bicicleta, a cavalo e até de carro com o propósito de agradecer ou de superar as dificuldades da própria vida. Saiba mais em https://caminhodafe.com.br/ptbr/.
ALENTEJO – PORTUGAL


murada e o CasteLo de eLvas

CatedraL e temPLo romano em évora





O Alentejo, maior região de Portugal, é um verdadeiro tesouro cultural com tradições preservadas ao longo dos séculos. Parte da região é considerada Patrimônio Cultural Imaterial da Humanidade e Patrimônio Mundial da Unesco, como as cidades de Évora e Elvas. A primeira tem mais de 2000 anos de história e é um verdadeiro museu a céu aberto, com monumentos como o Templo Romano, a Catedral e a Capela dos Ossos. Elvas é uma cidade-quarteirão fronteiriça com um conjunto de fortificações que incluem as muralhas abaluartadas e outros monumentos militares. Entre as manifestações culturais imateriais do Alentejo estão o Cante Alentejano, gênero de canto tradicional executado por grupos corais amadores; a Fabricação de Chocalhos, tradicionais sinos utilizados nos rebanhos rurais; e a produção do Figurado em Barro de Estremoz, figuras feitas de argila, queimadas em fornos e pintadas à mão. O vinho de talha também é considerado uma tradição da região. Saiba mais em www.visitalentejo.pt/pt/.
Os profissionais da saúde que desejarem receber a revista Super Saudável devem enviar dados pessoais, Conselho Regional e especialidade para o e-mail cacy@yakult.com.br
Quem já recebe deve manter o cadastro com os dados atualizados. Todas as edições estão disponíveis nos sites www.yakult.com.br e www.revistasupersaudavel.com.br
A equipe da Super Saudável quer saber a sua opinião sobre a publicação, assim como receber sugestões e comentários.
Escreva para: Rua José Versolato, 111 – Cj 1024 – Bloco B
Centro – São Bernardo do Campo – SP – CEP 09750-730
Mande e-mail para: adbringel@companhiadeimprensa.com.br
Ligue para: (11) 4432-4000
Os interessados em obter telefones e endereços dos profissionais entrevistados devem entrar em contato pelo telefone







































































